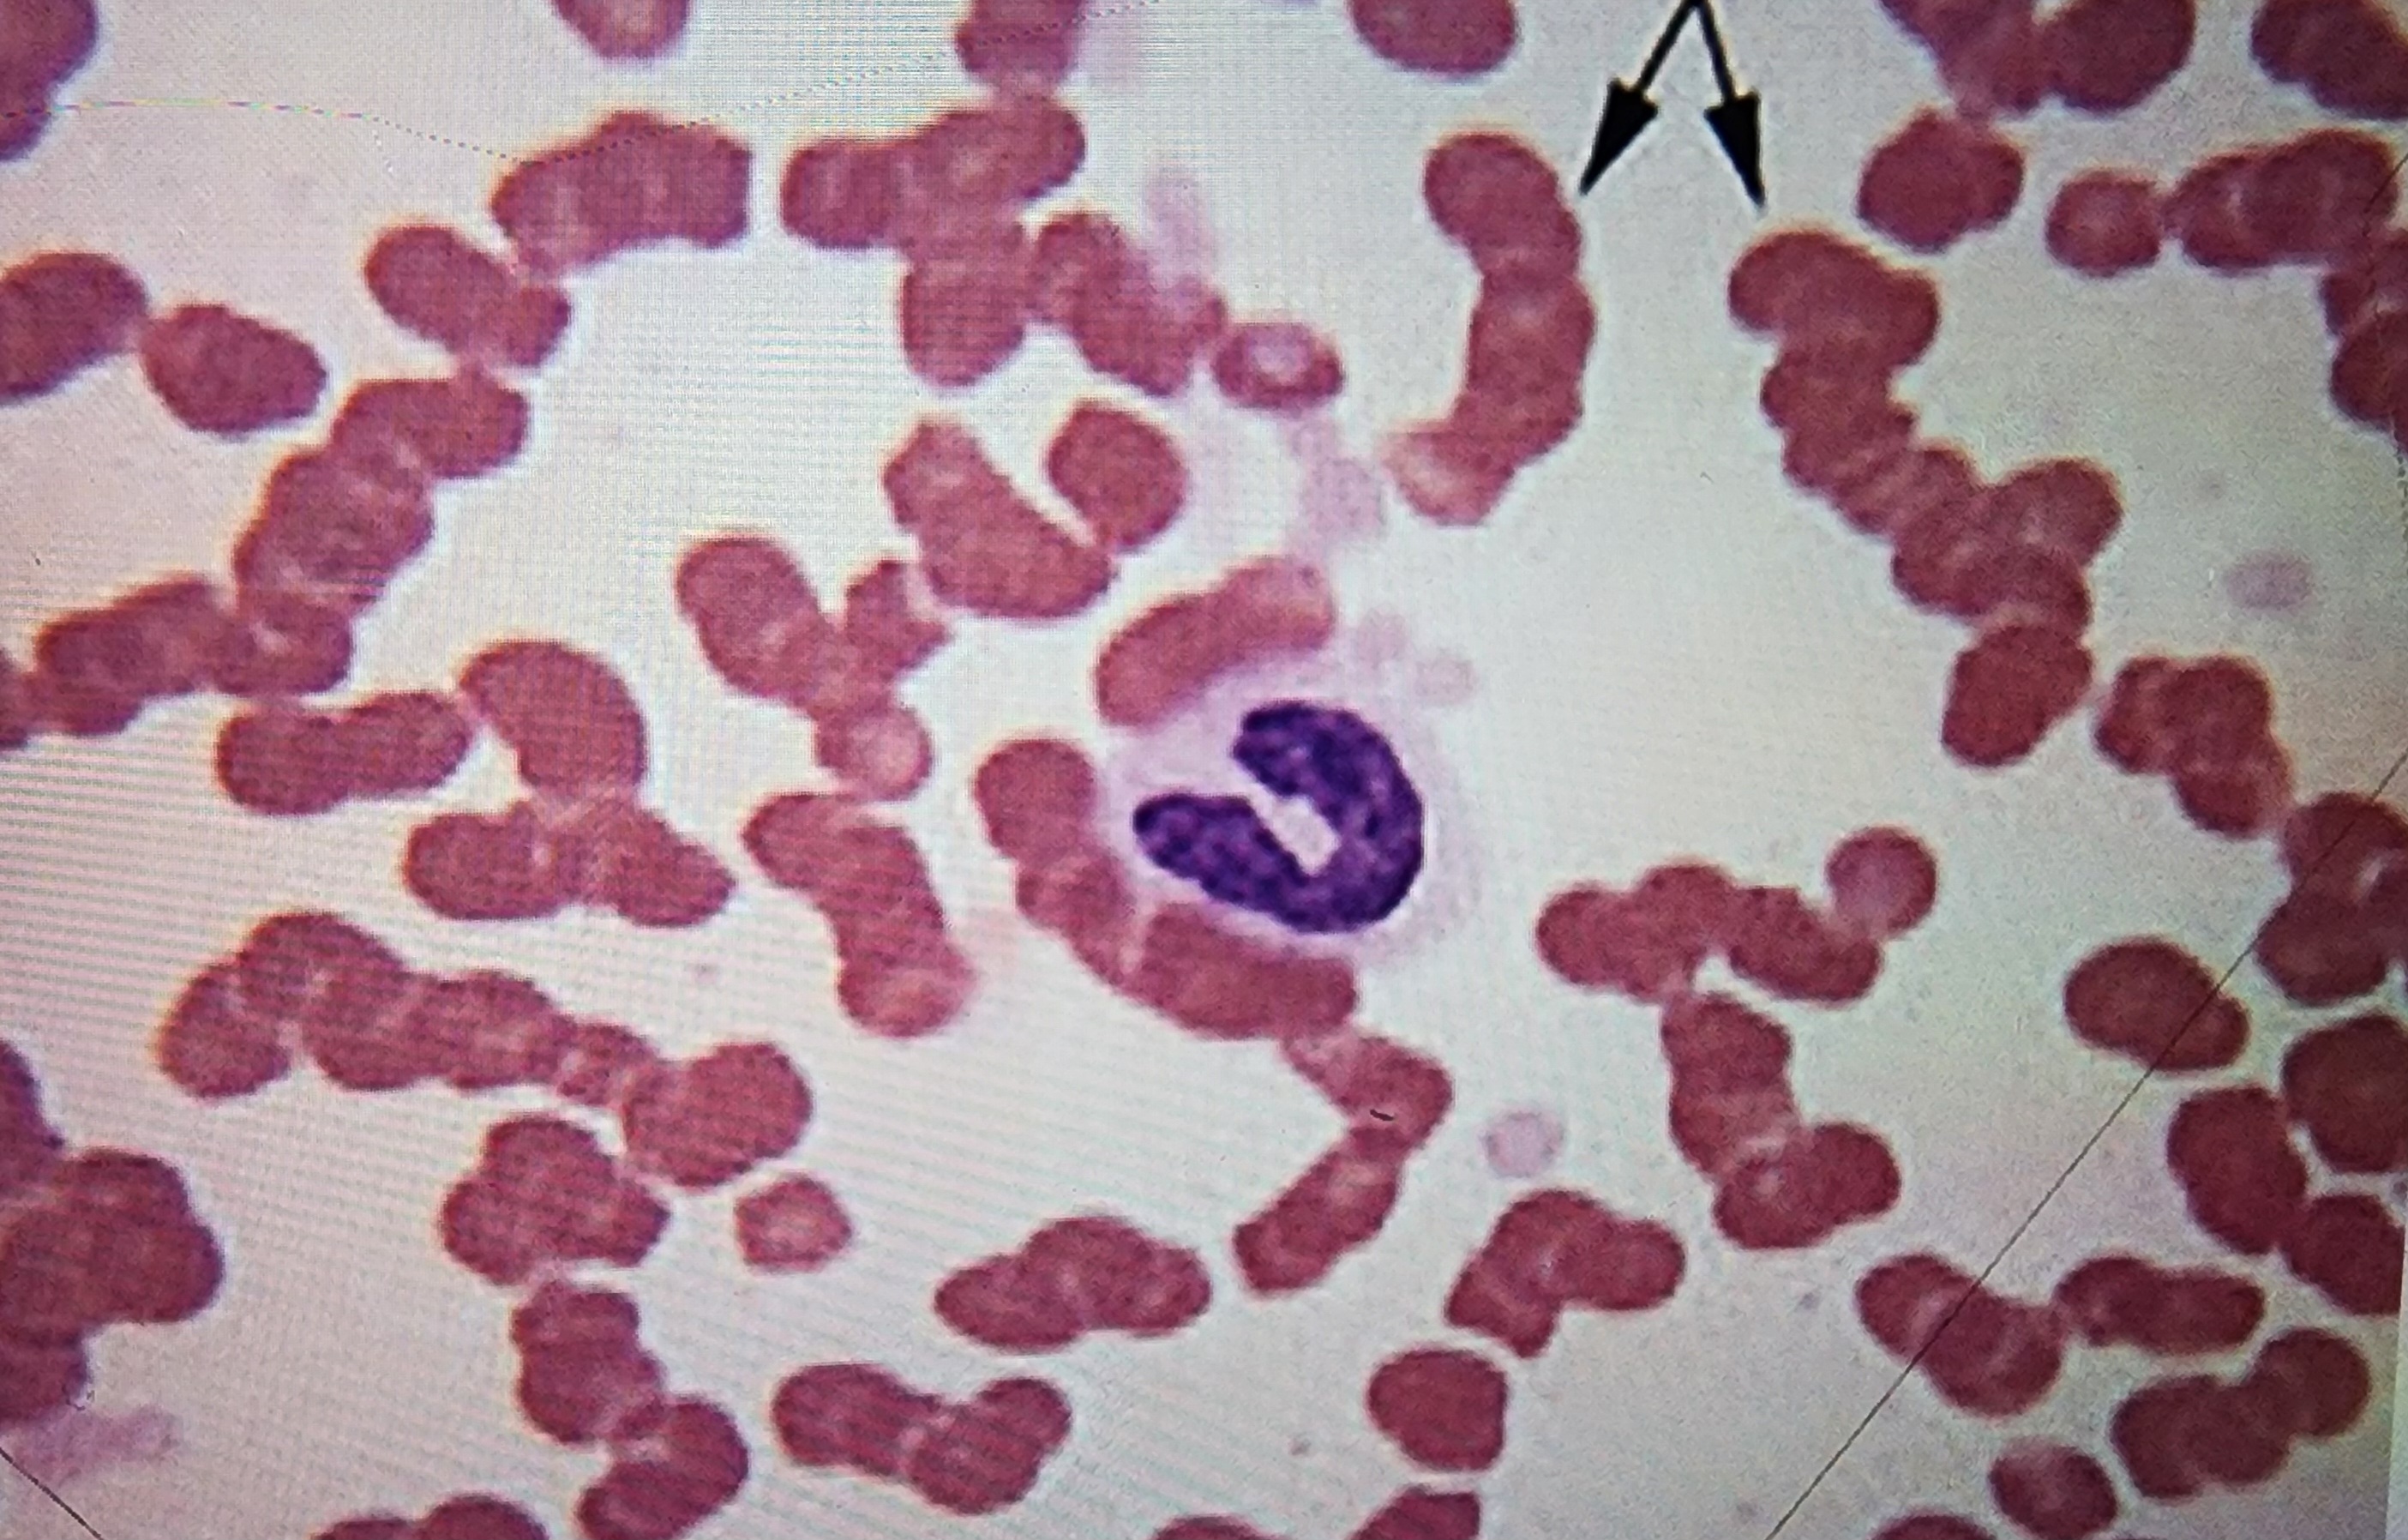
<p>coin stacking</p>
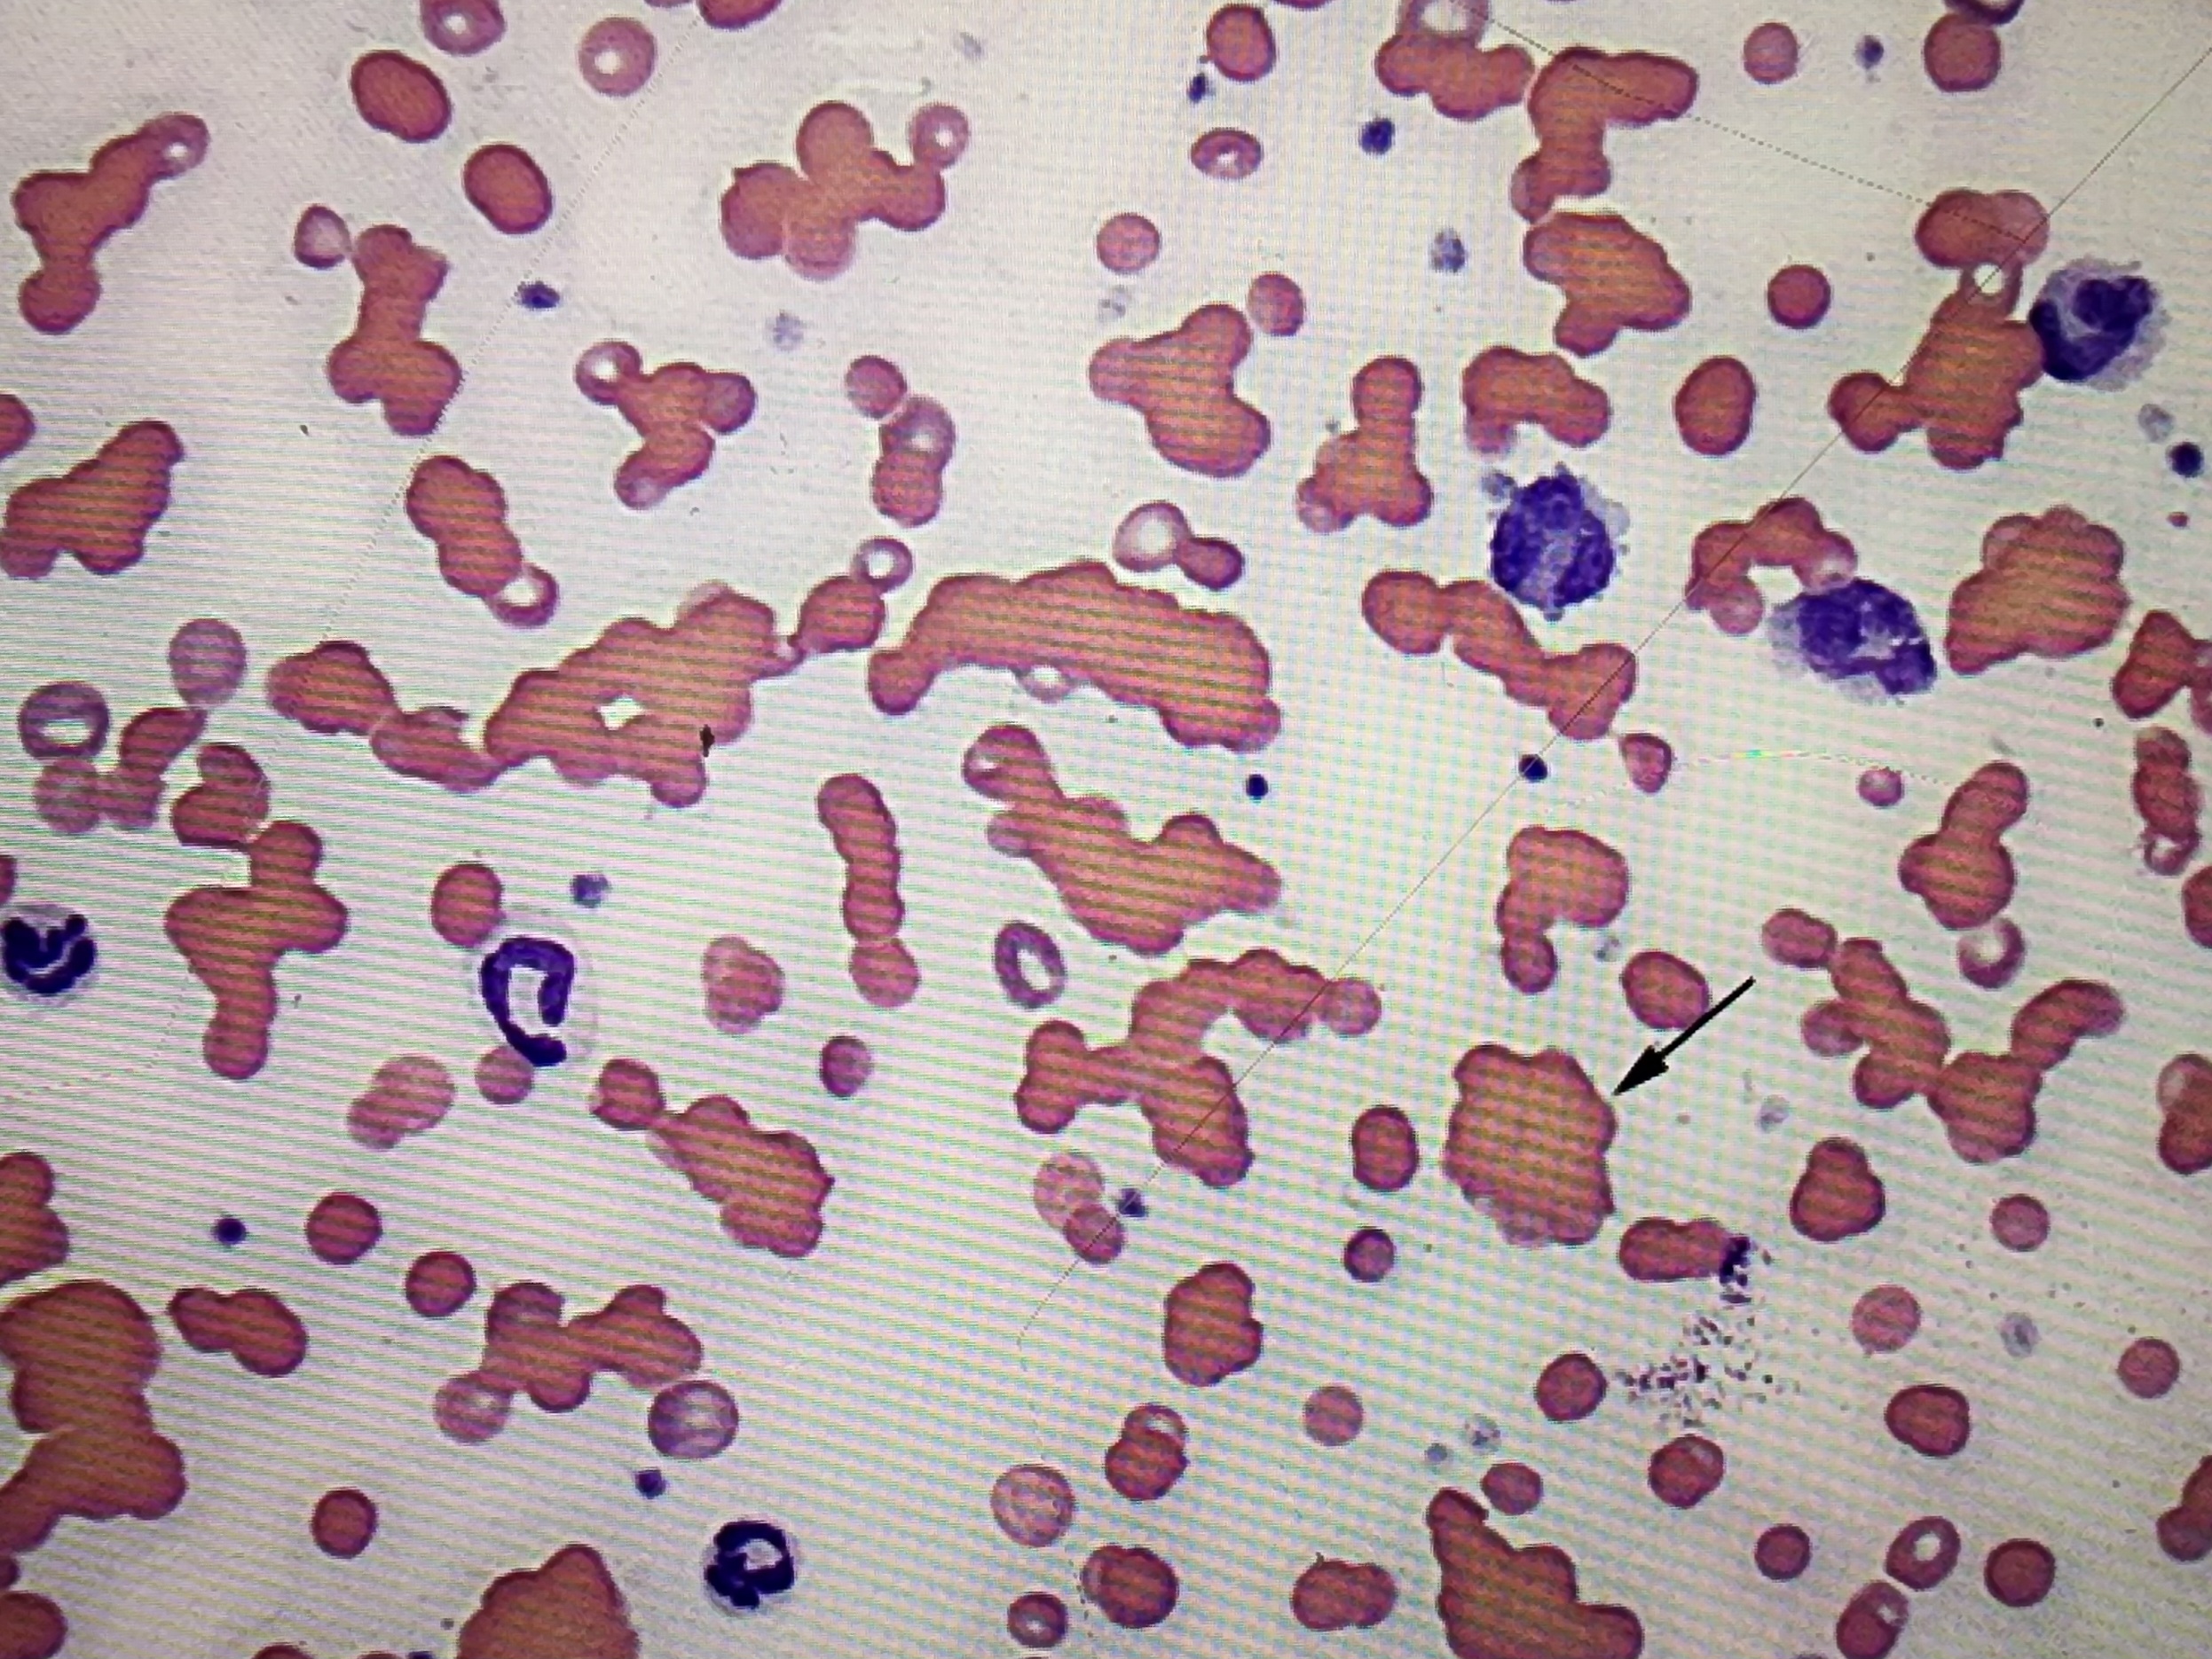
<p>clumping</p>
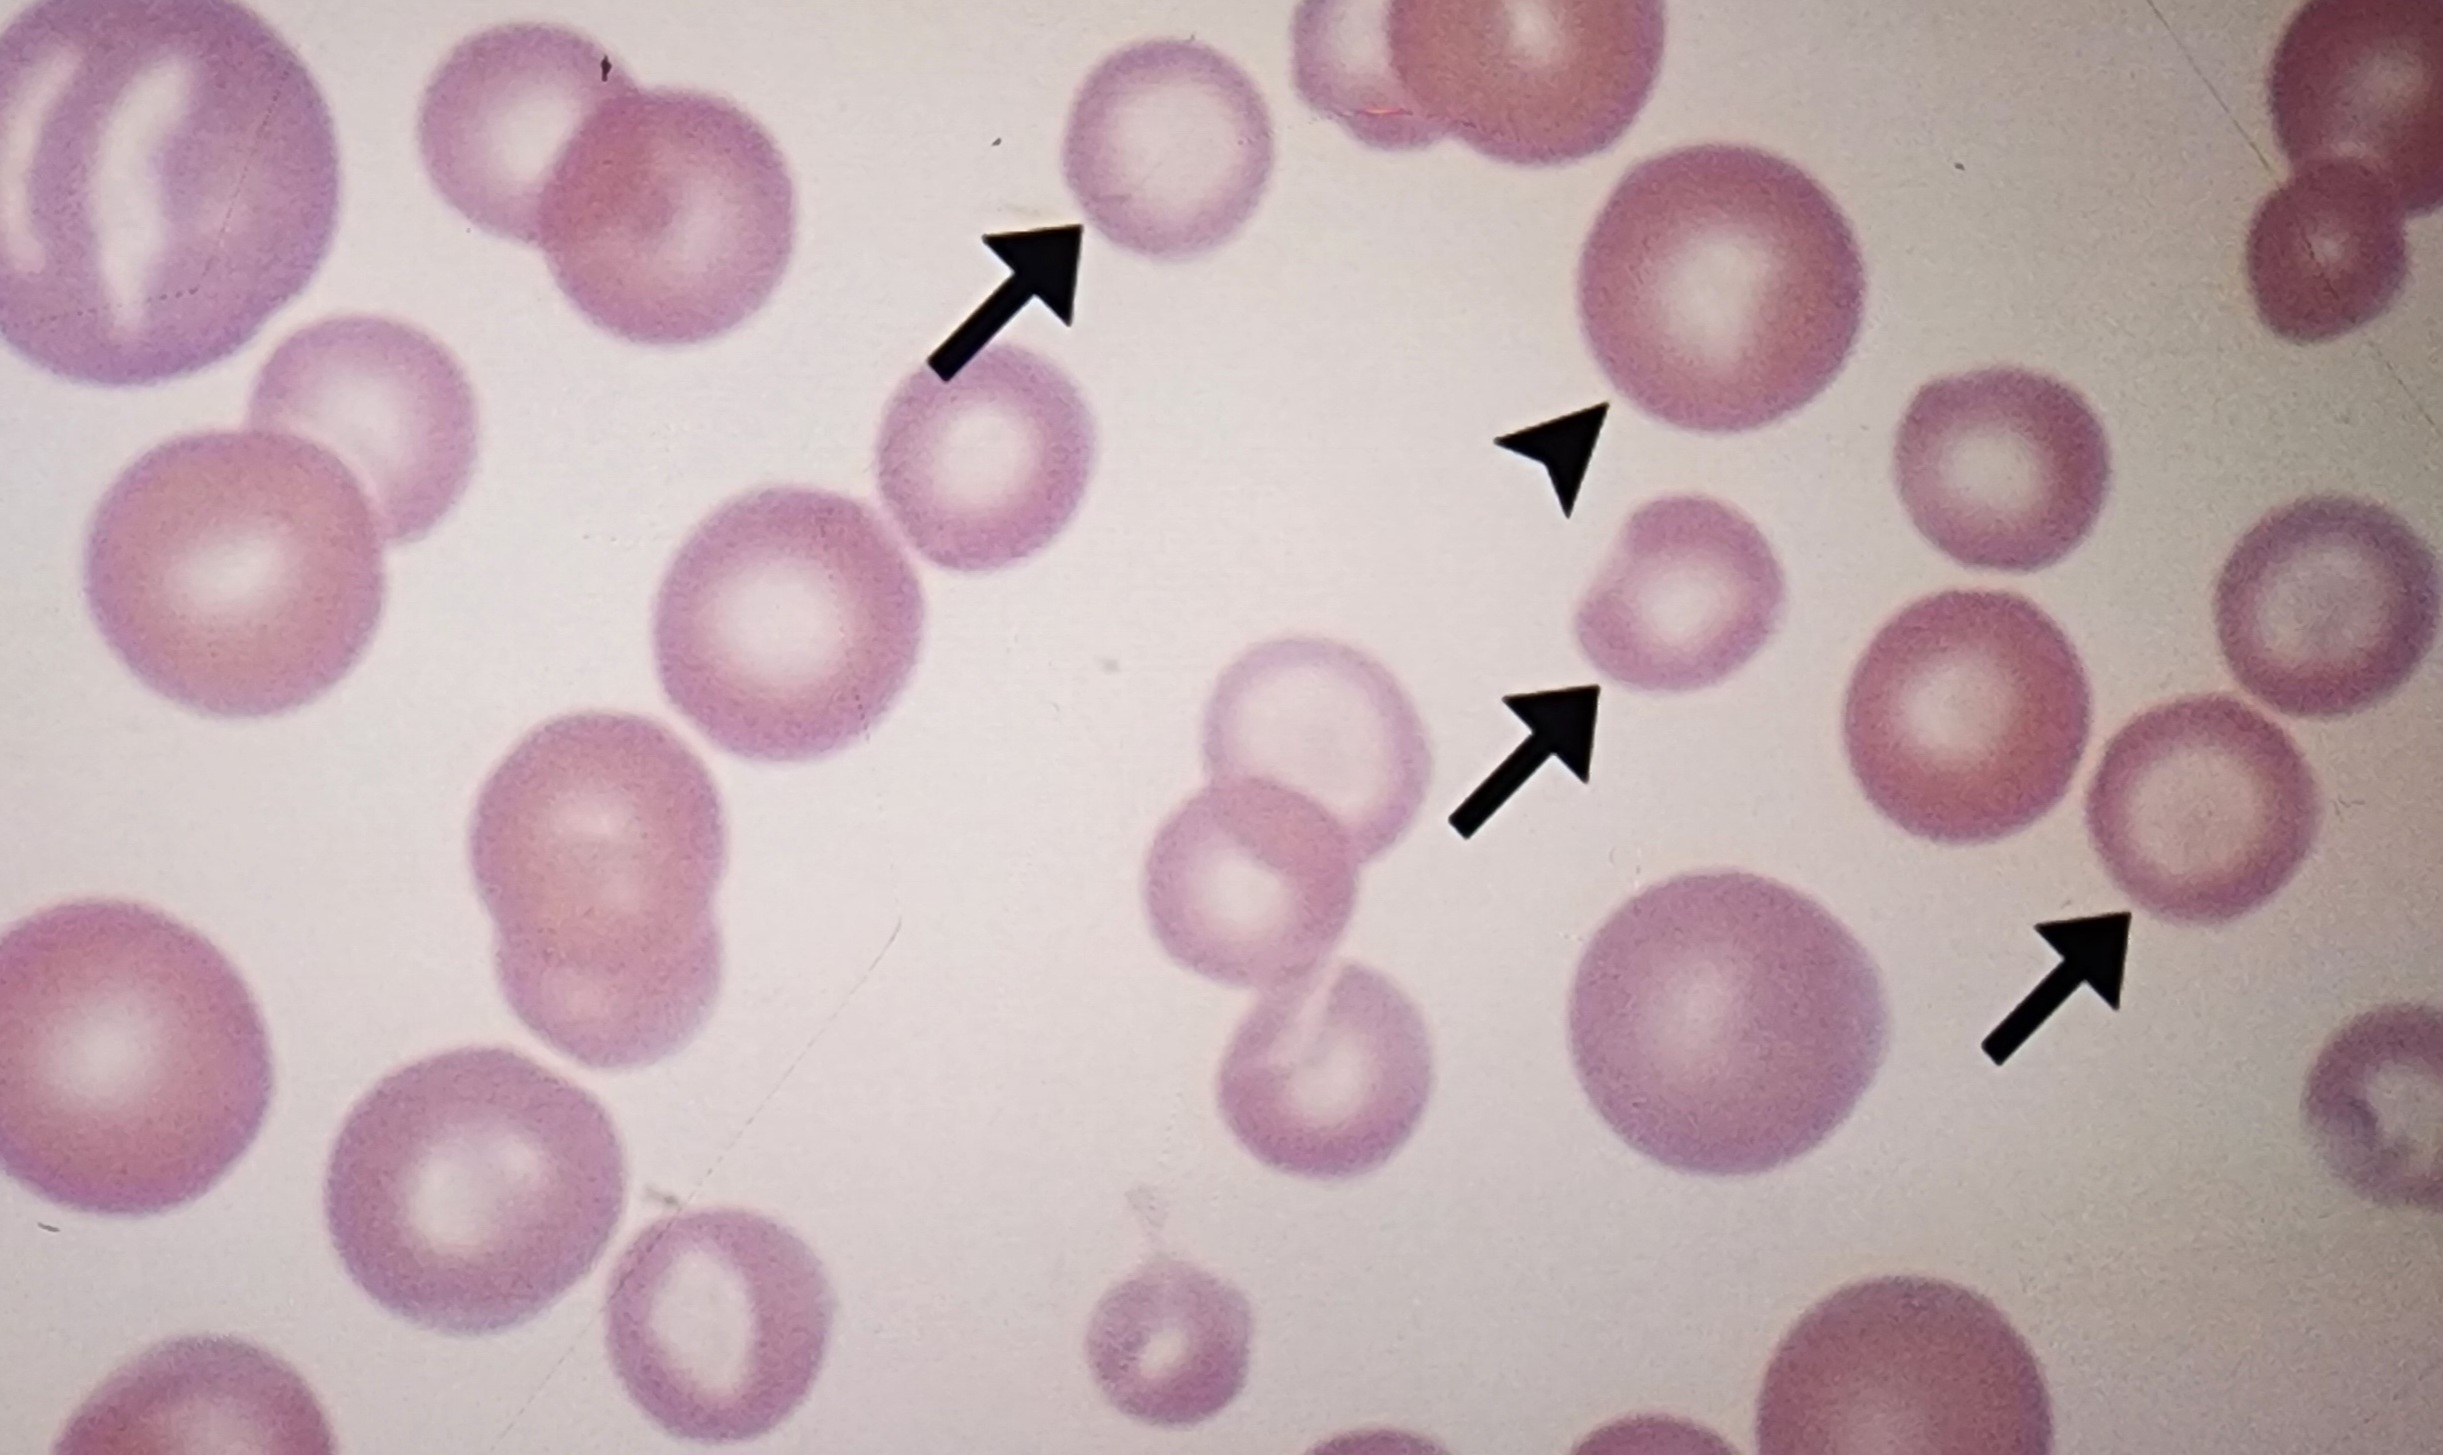
knowt flashcard image
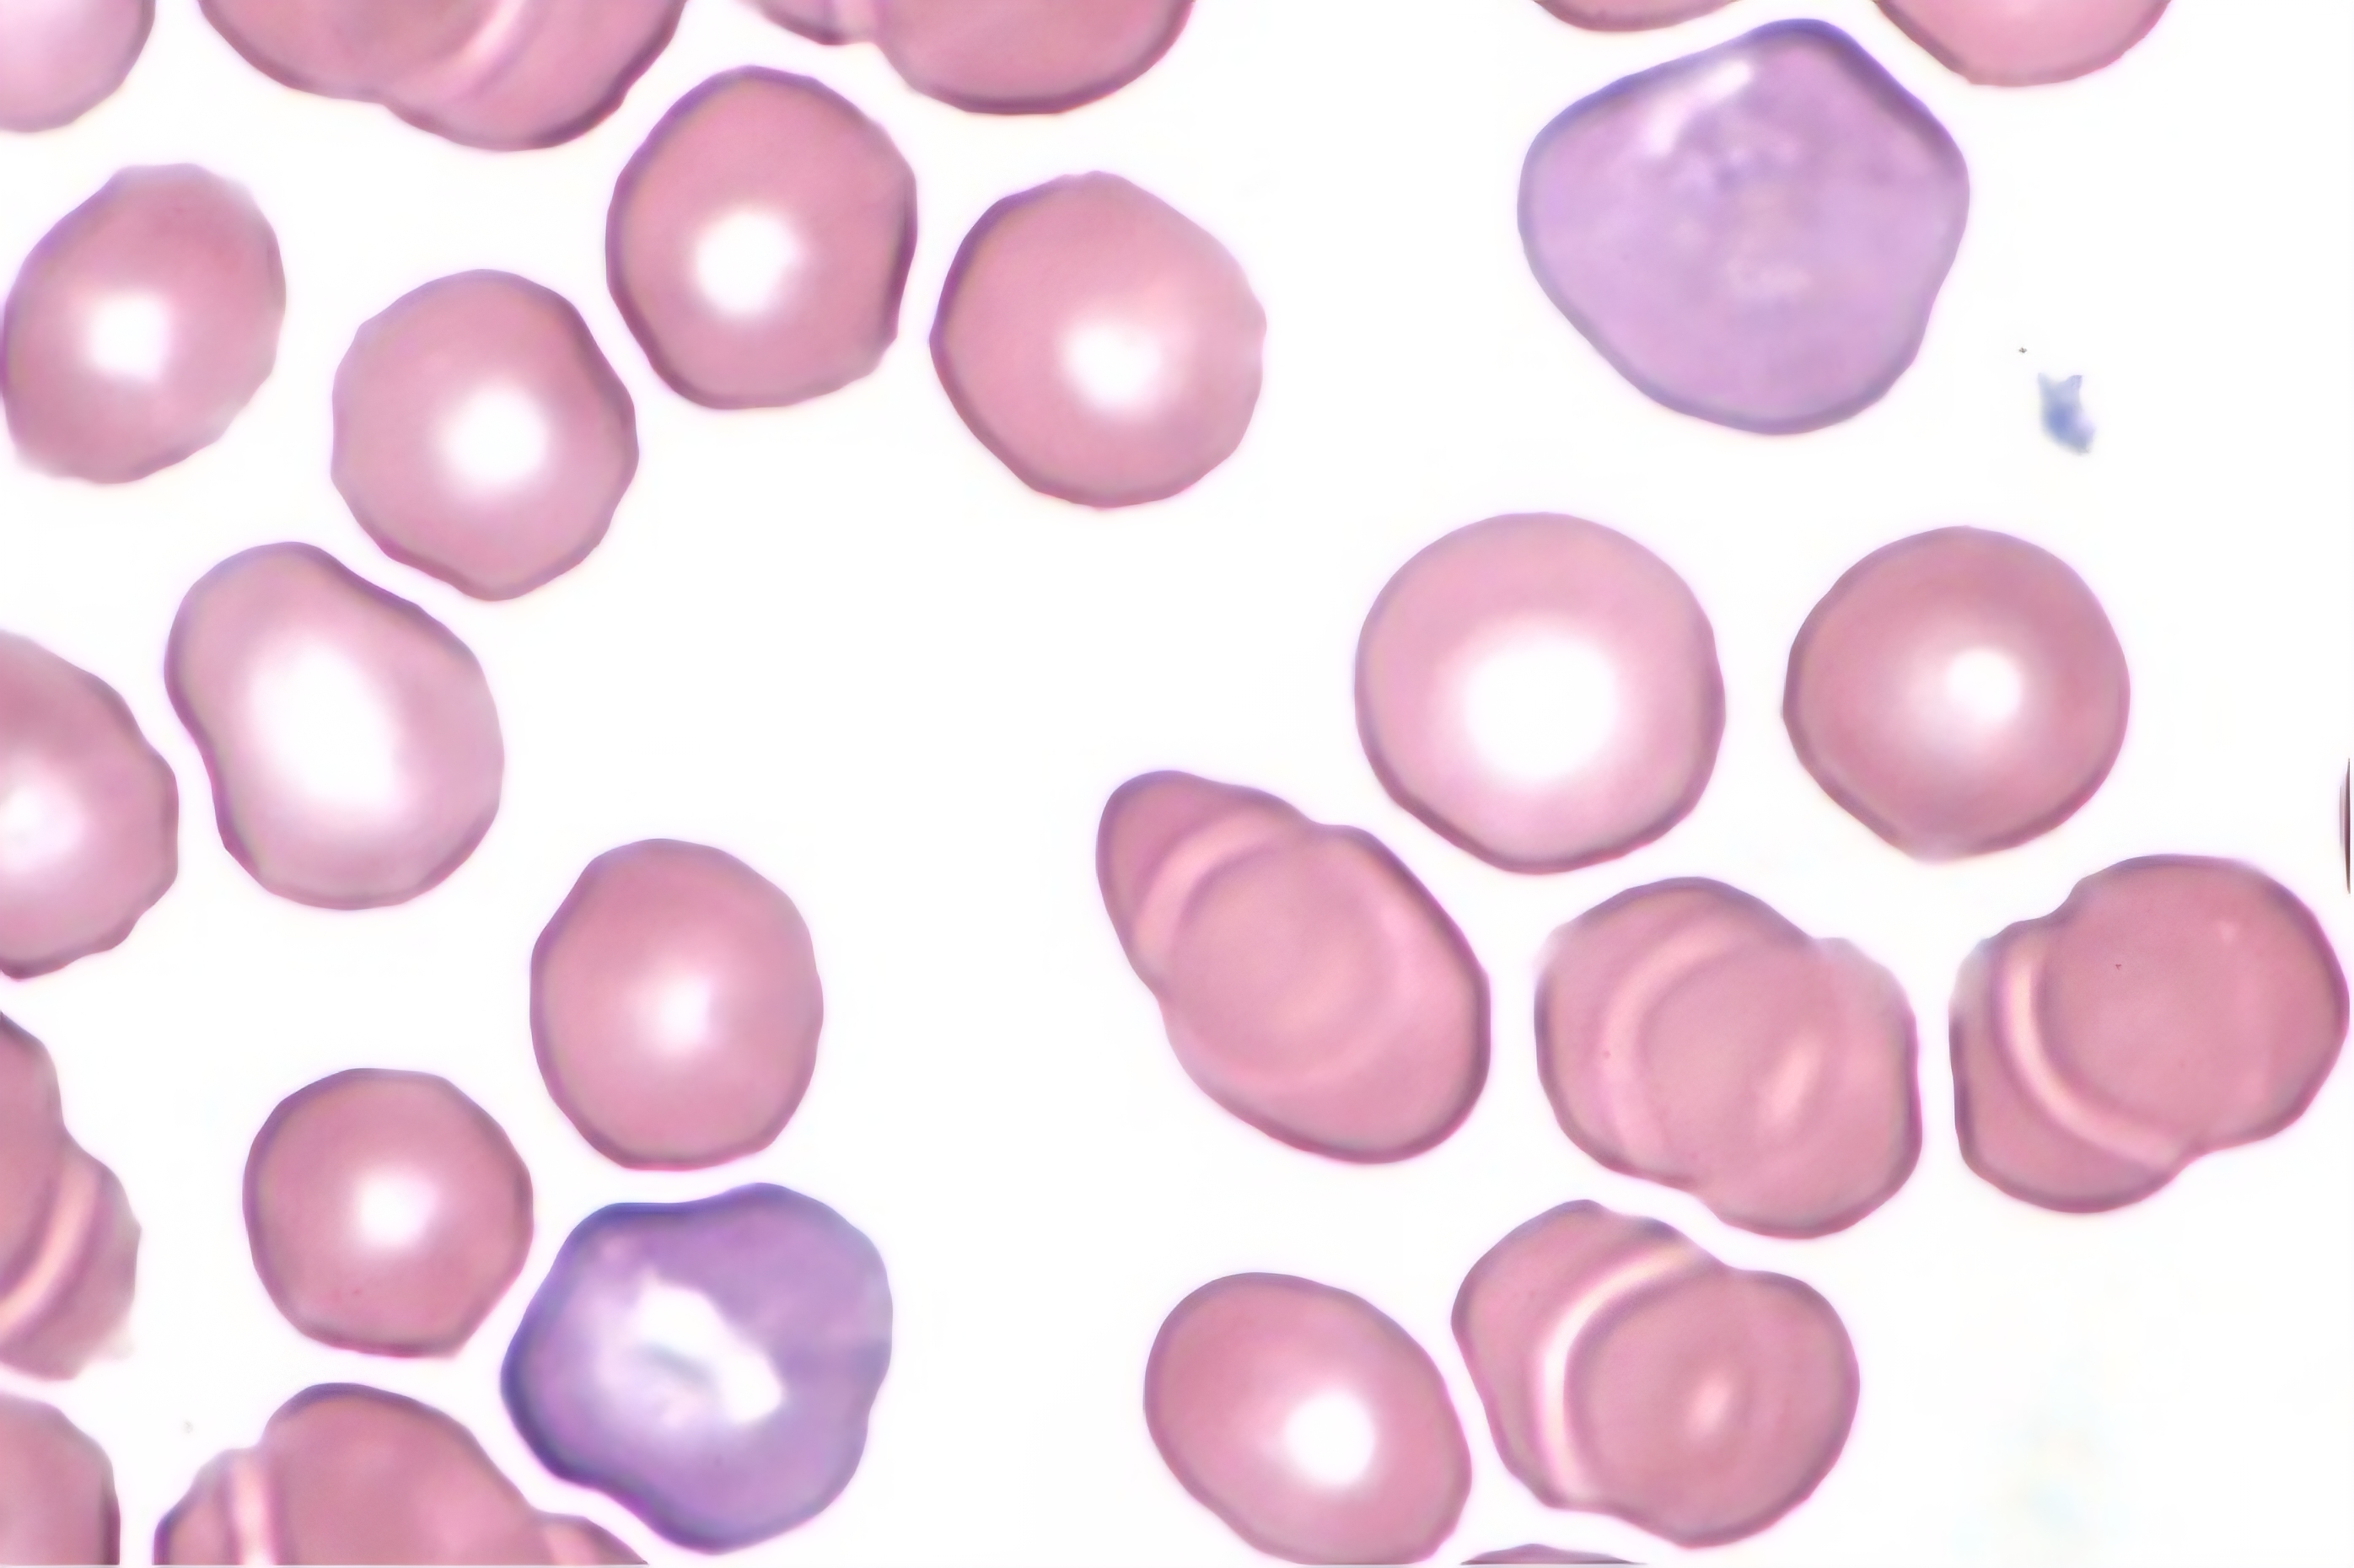
<p>RBCs with no central palor and bigger</p>
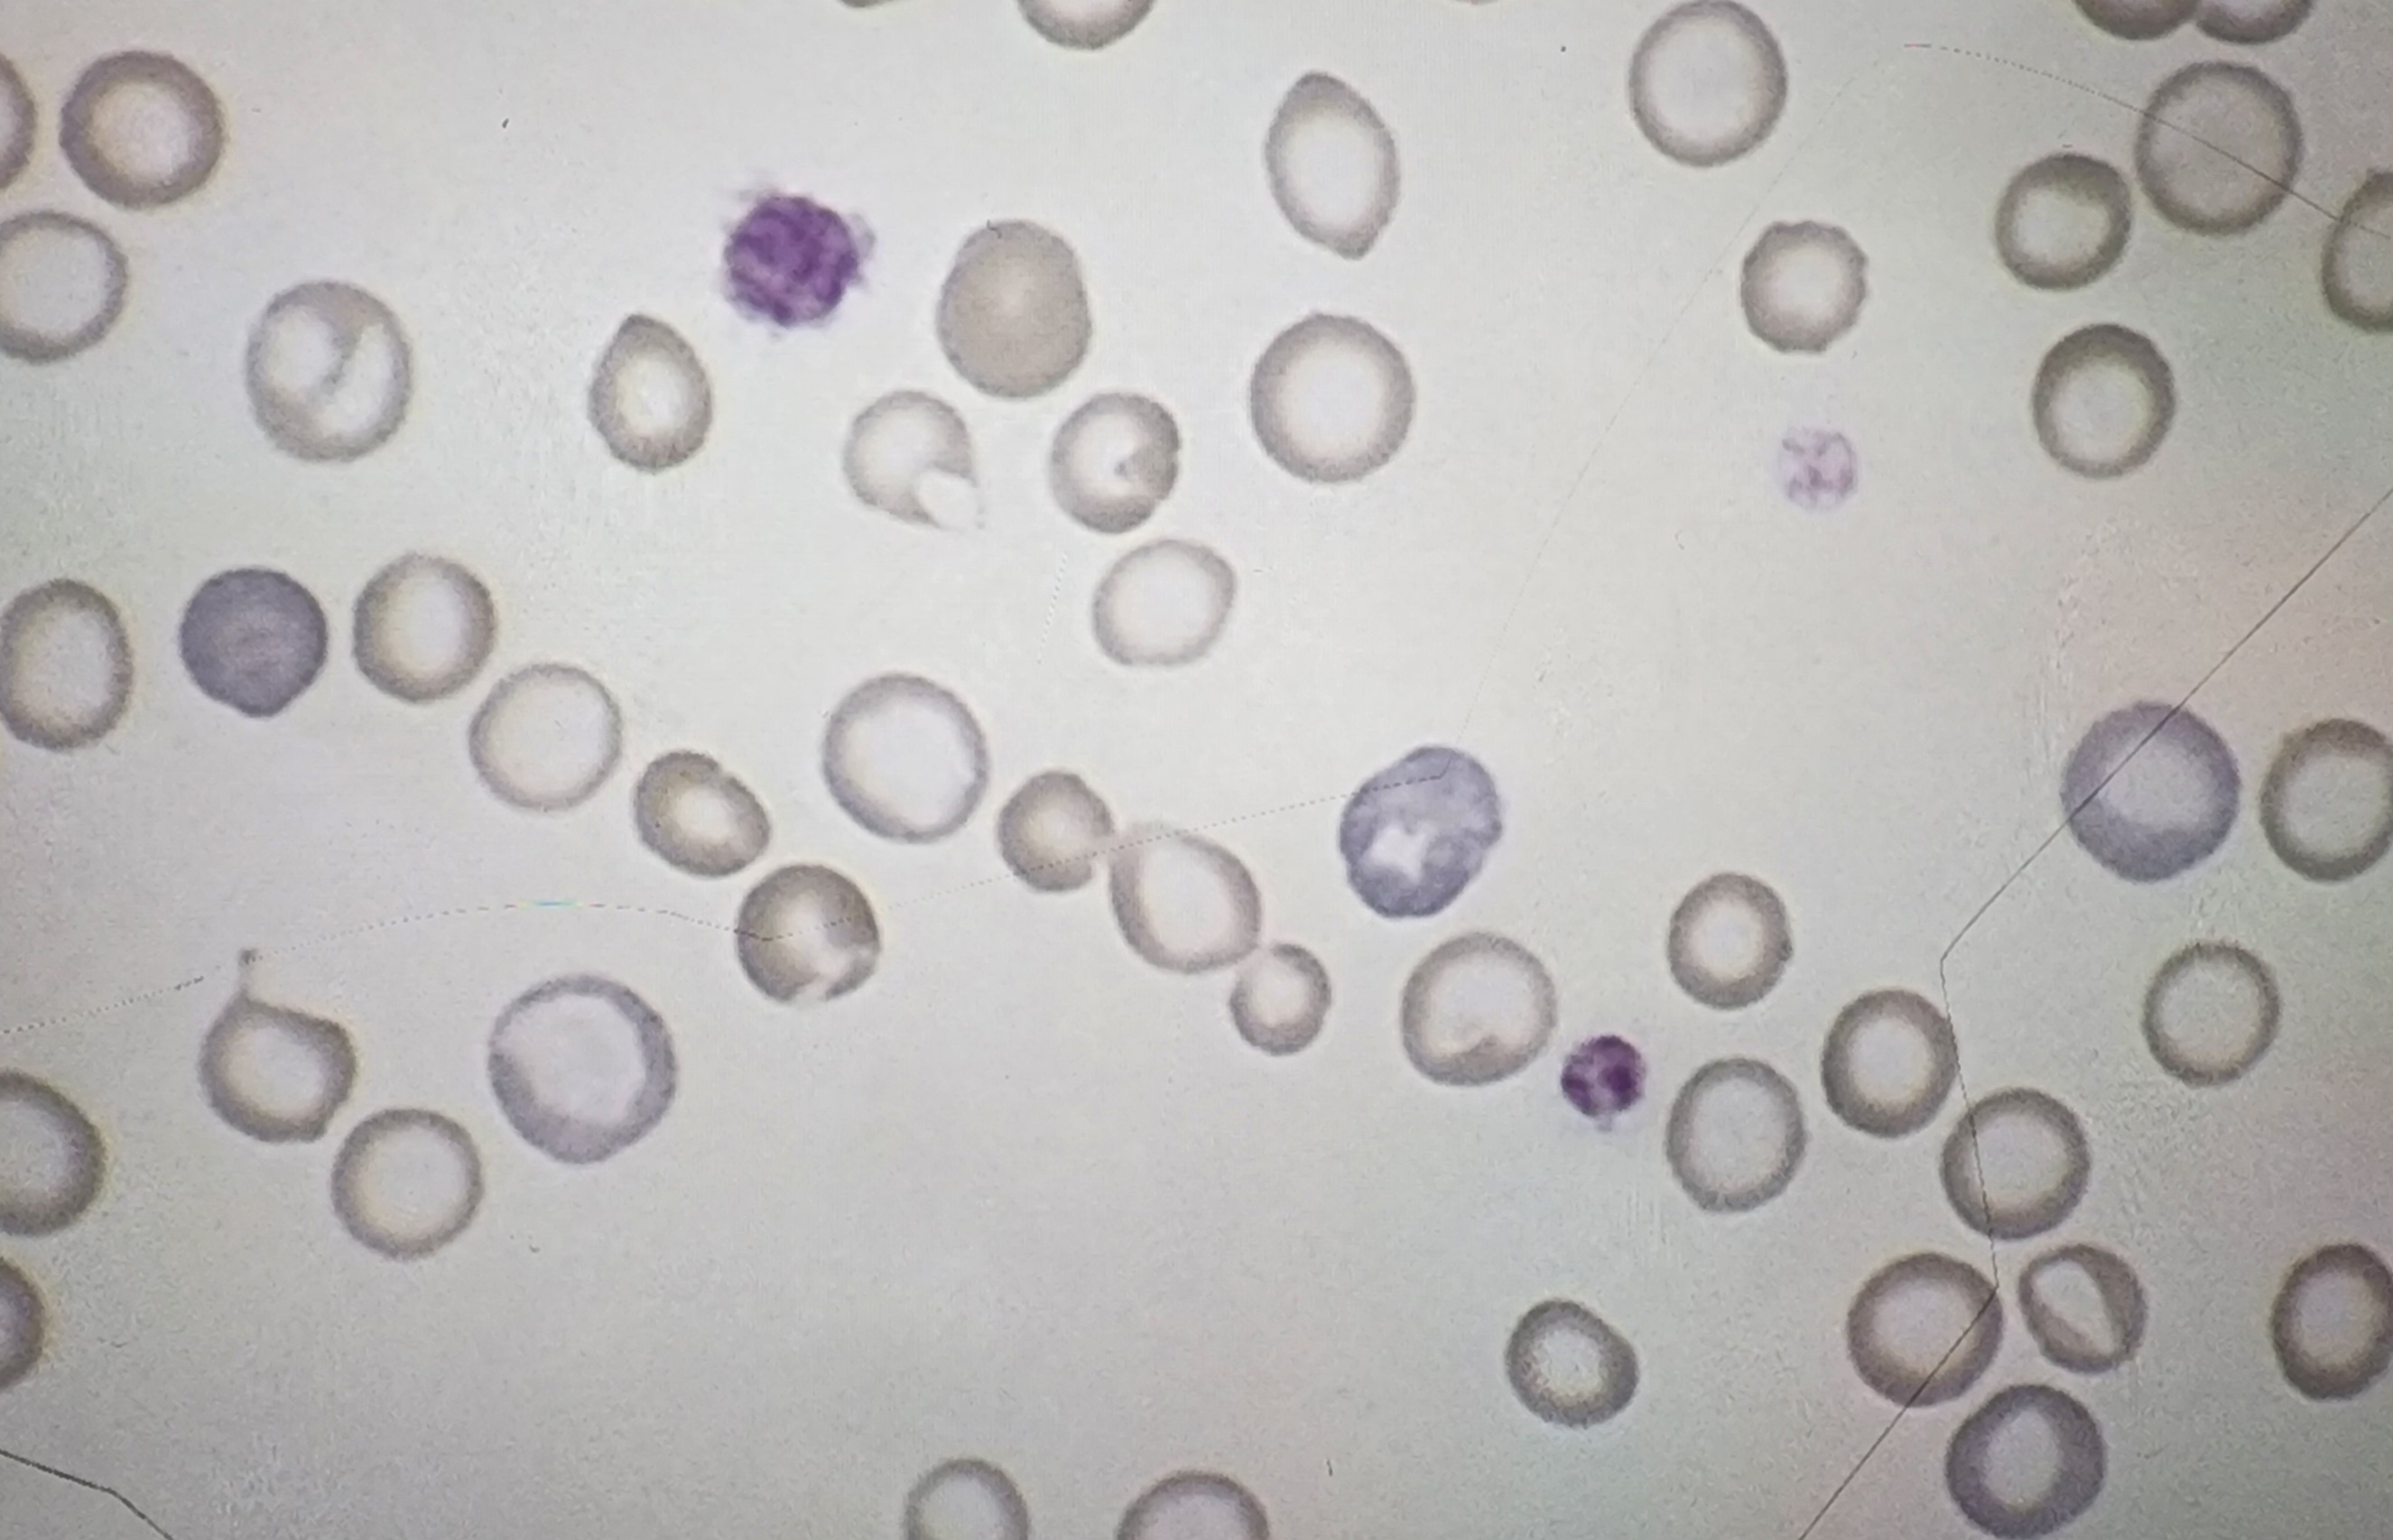
<p>RBCs with less color</p>
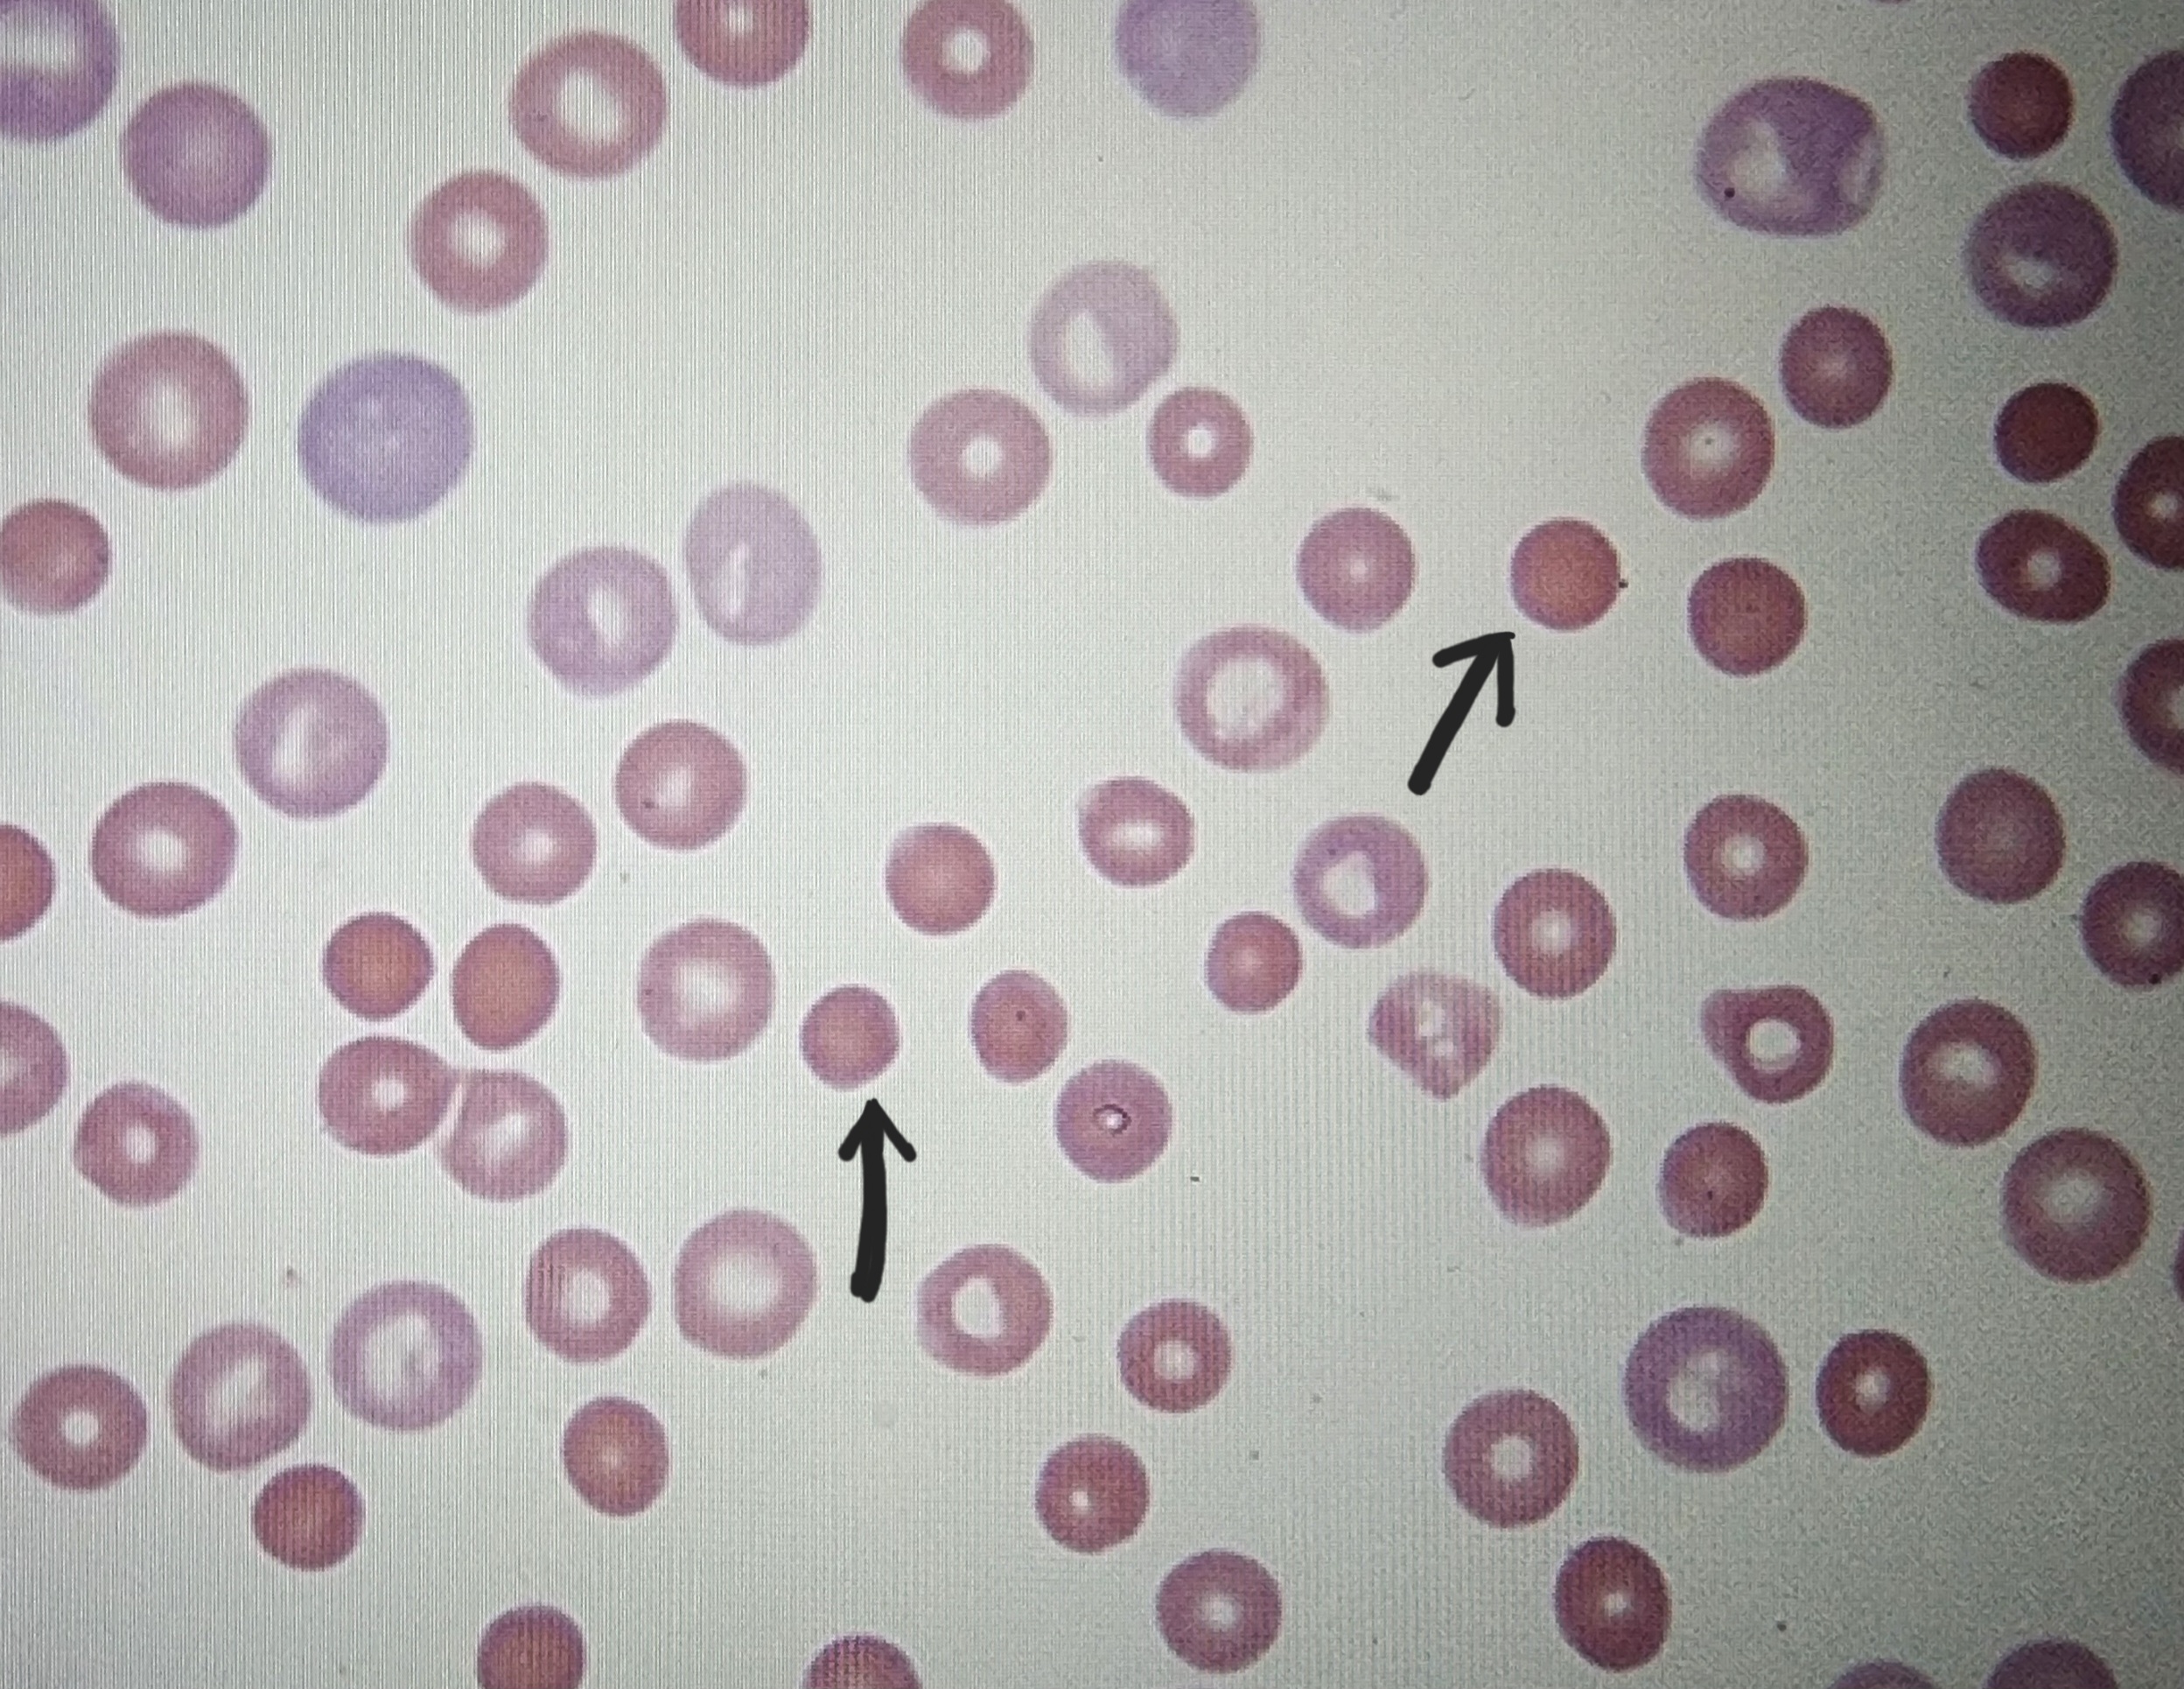
<p>has hyperchromatophil</p>
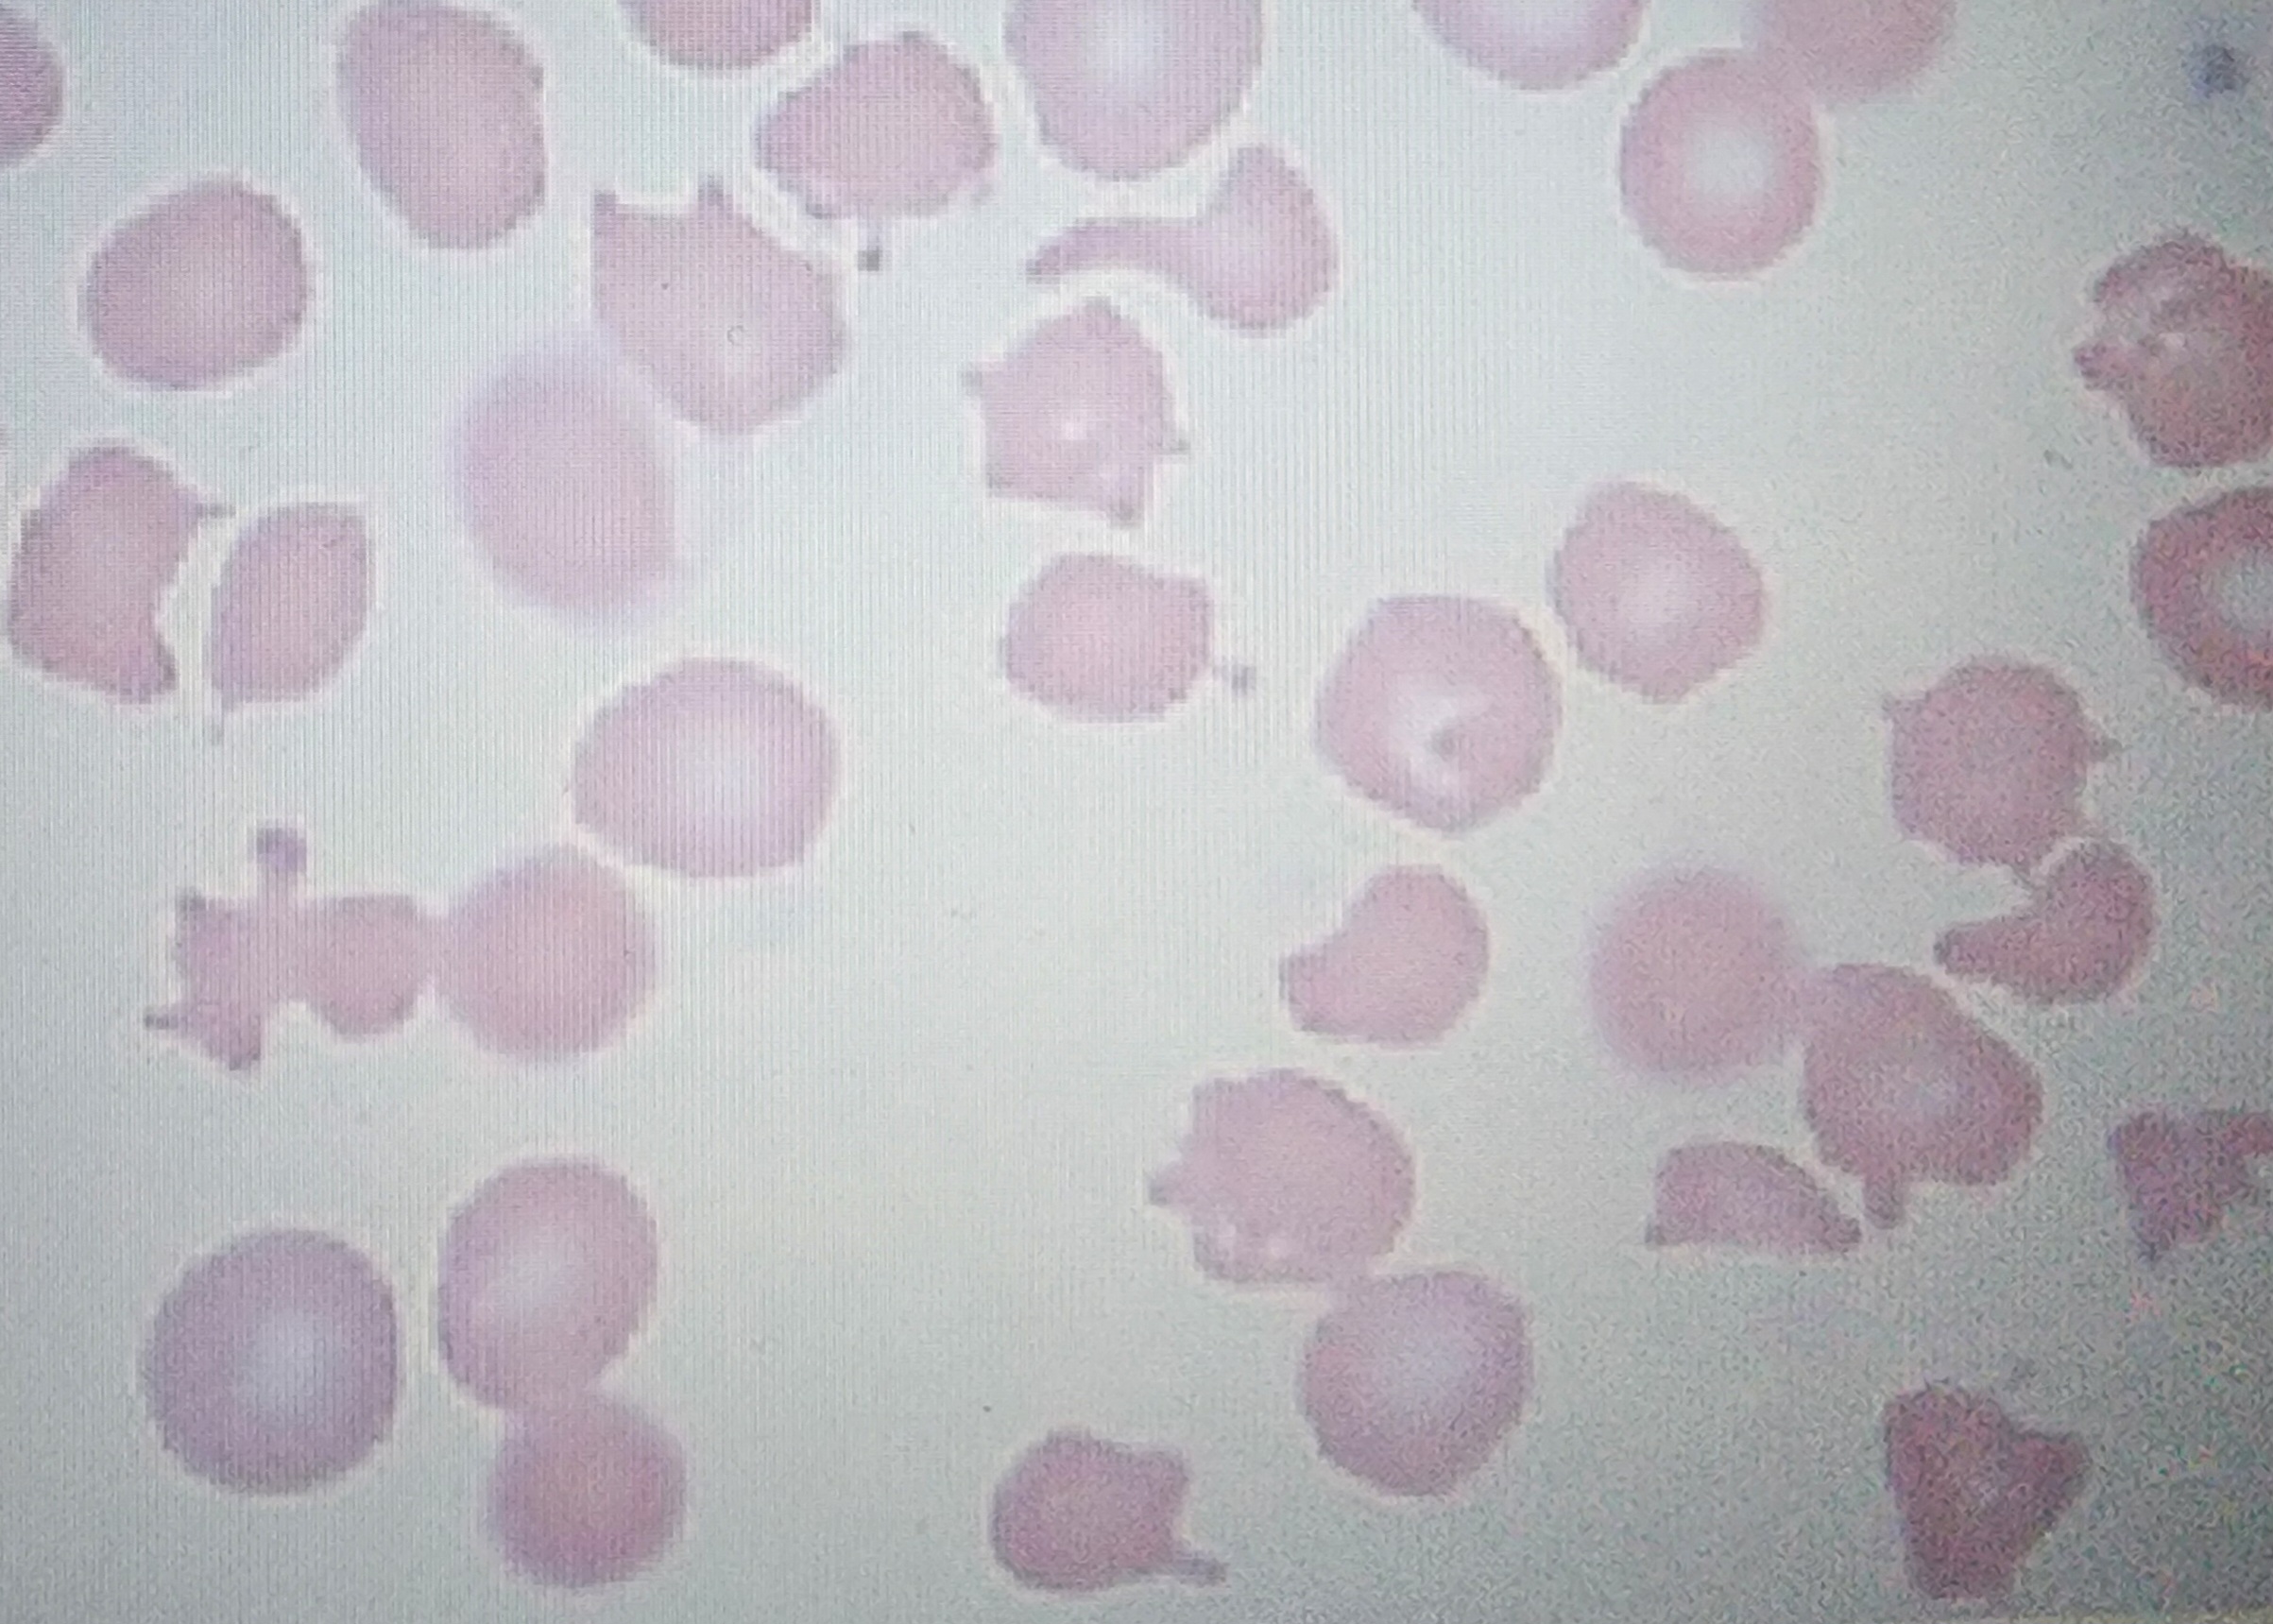
<p>generic term for any abnormalities</p>
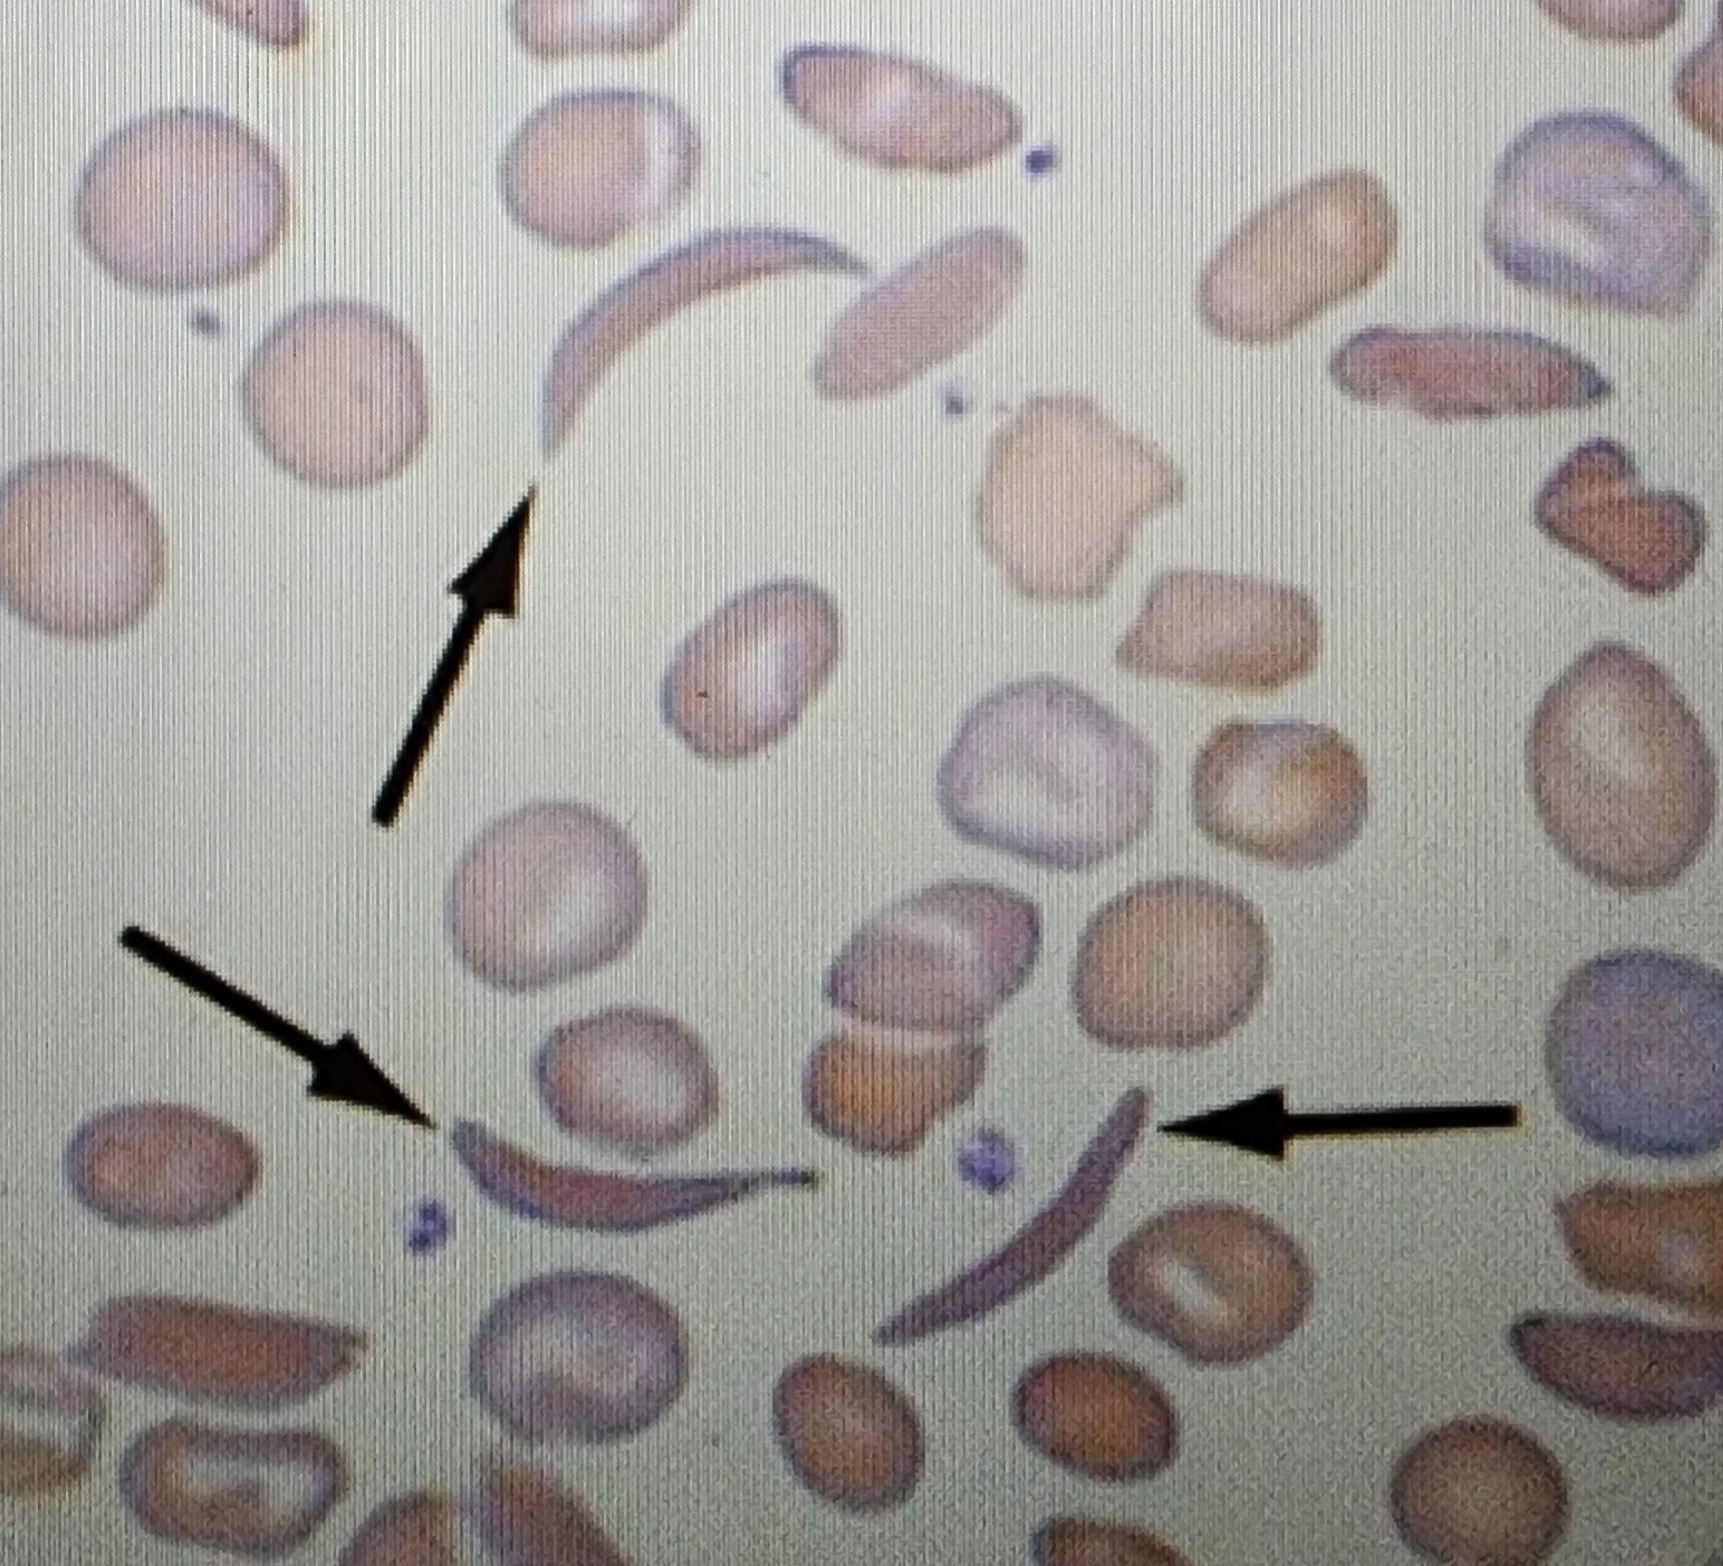
<p>Sickle shaped when blood is exposed to air </p>
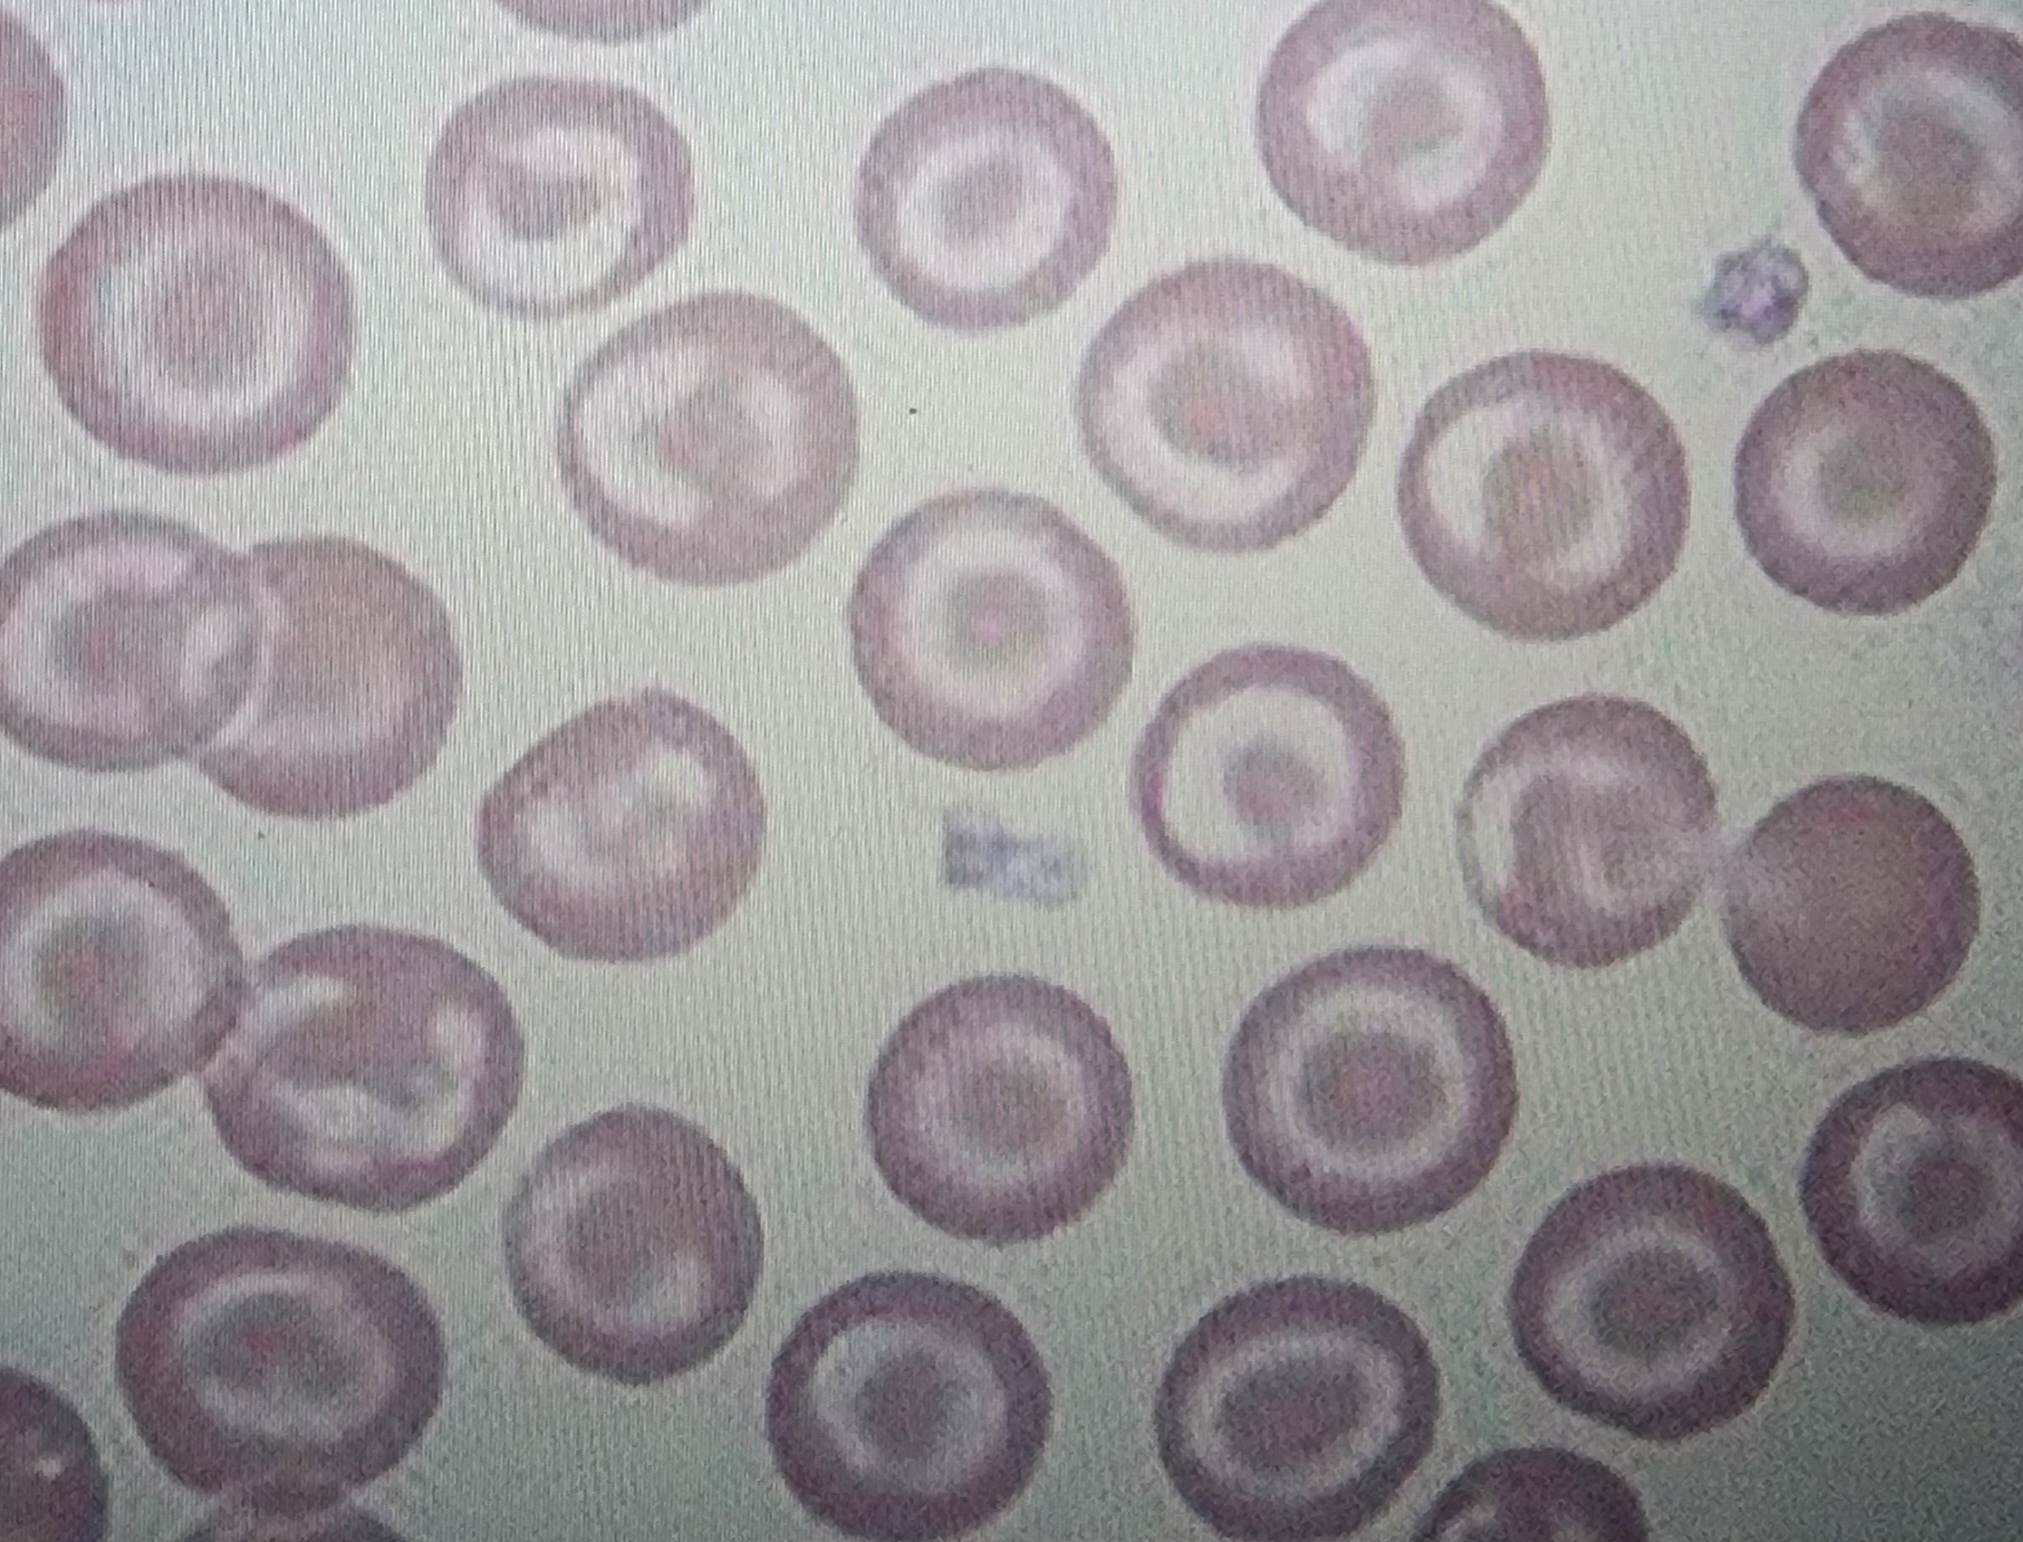
<p>Target cells</p>
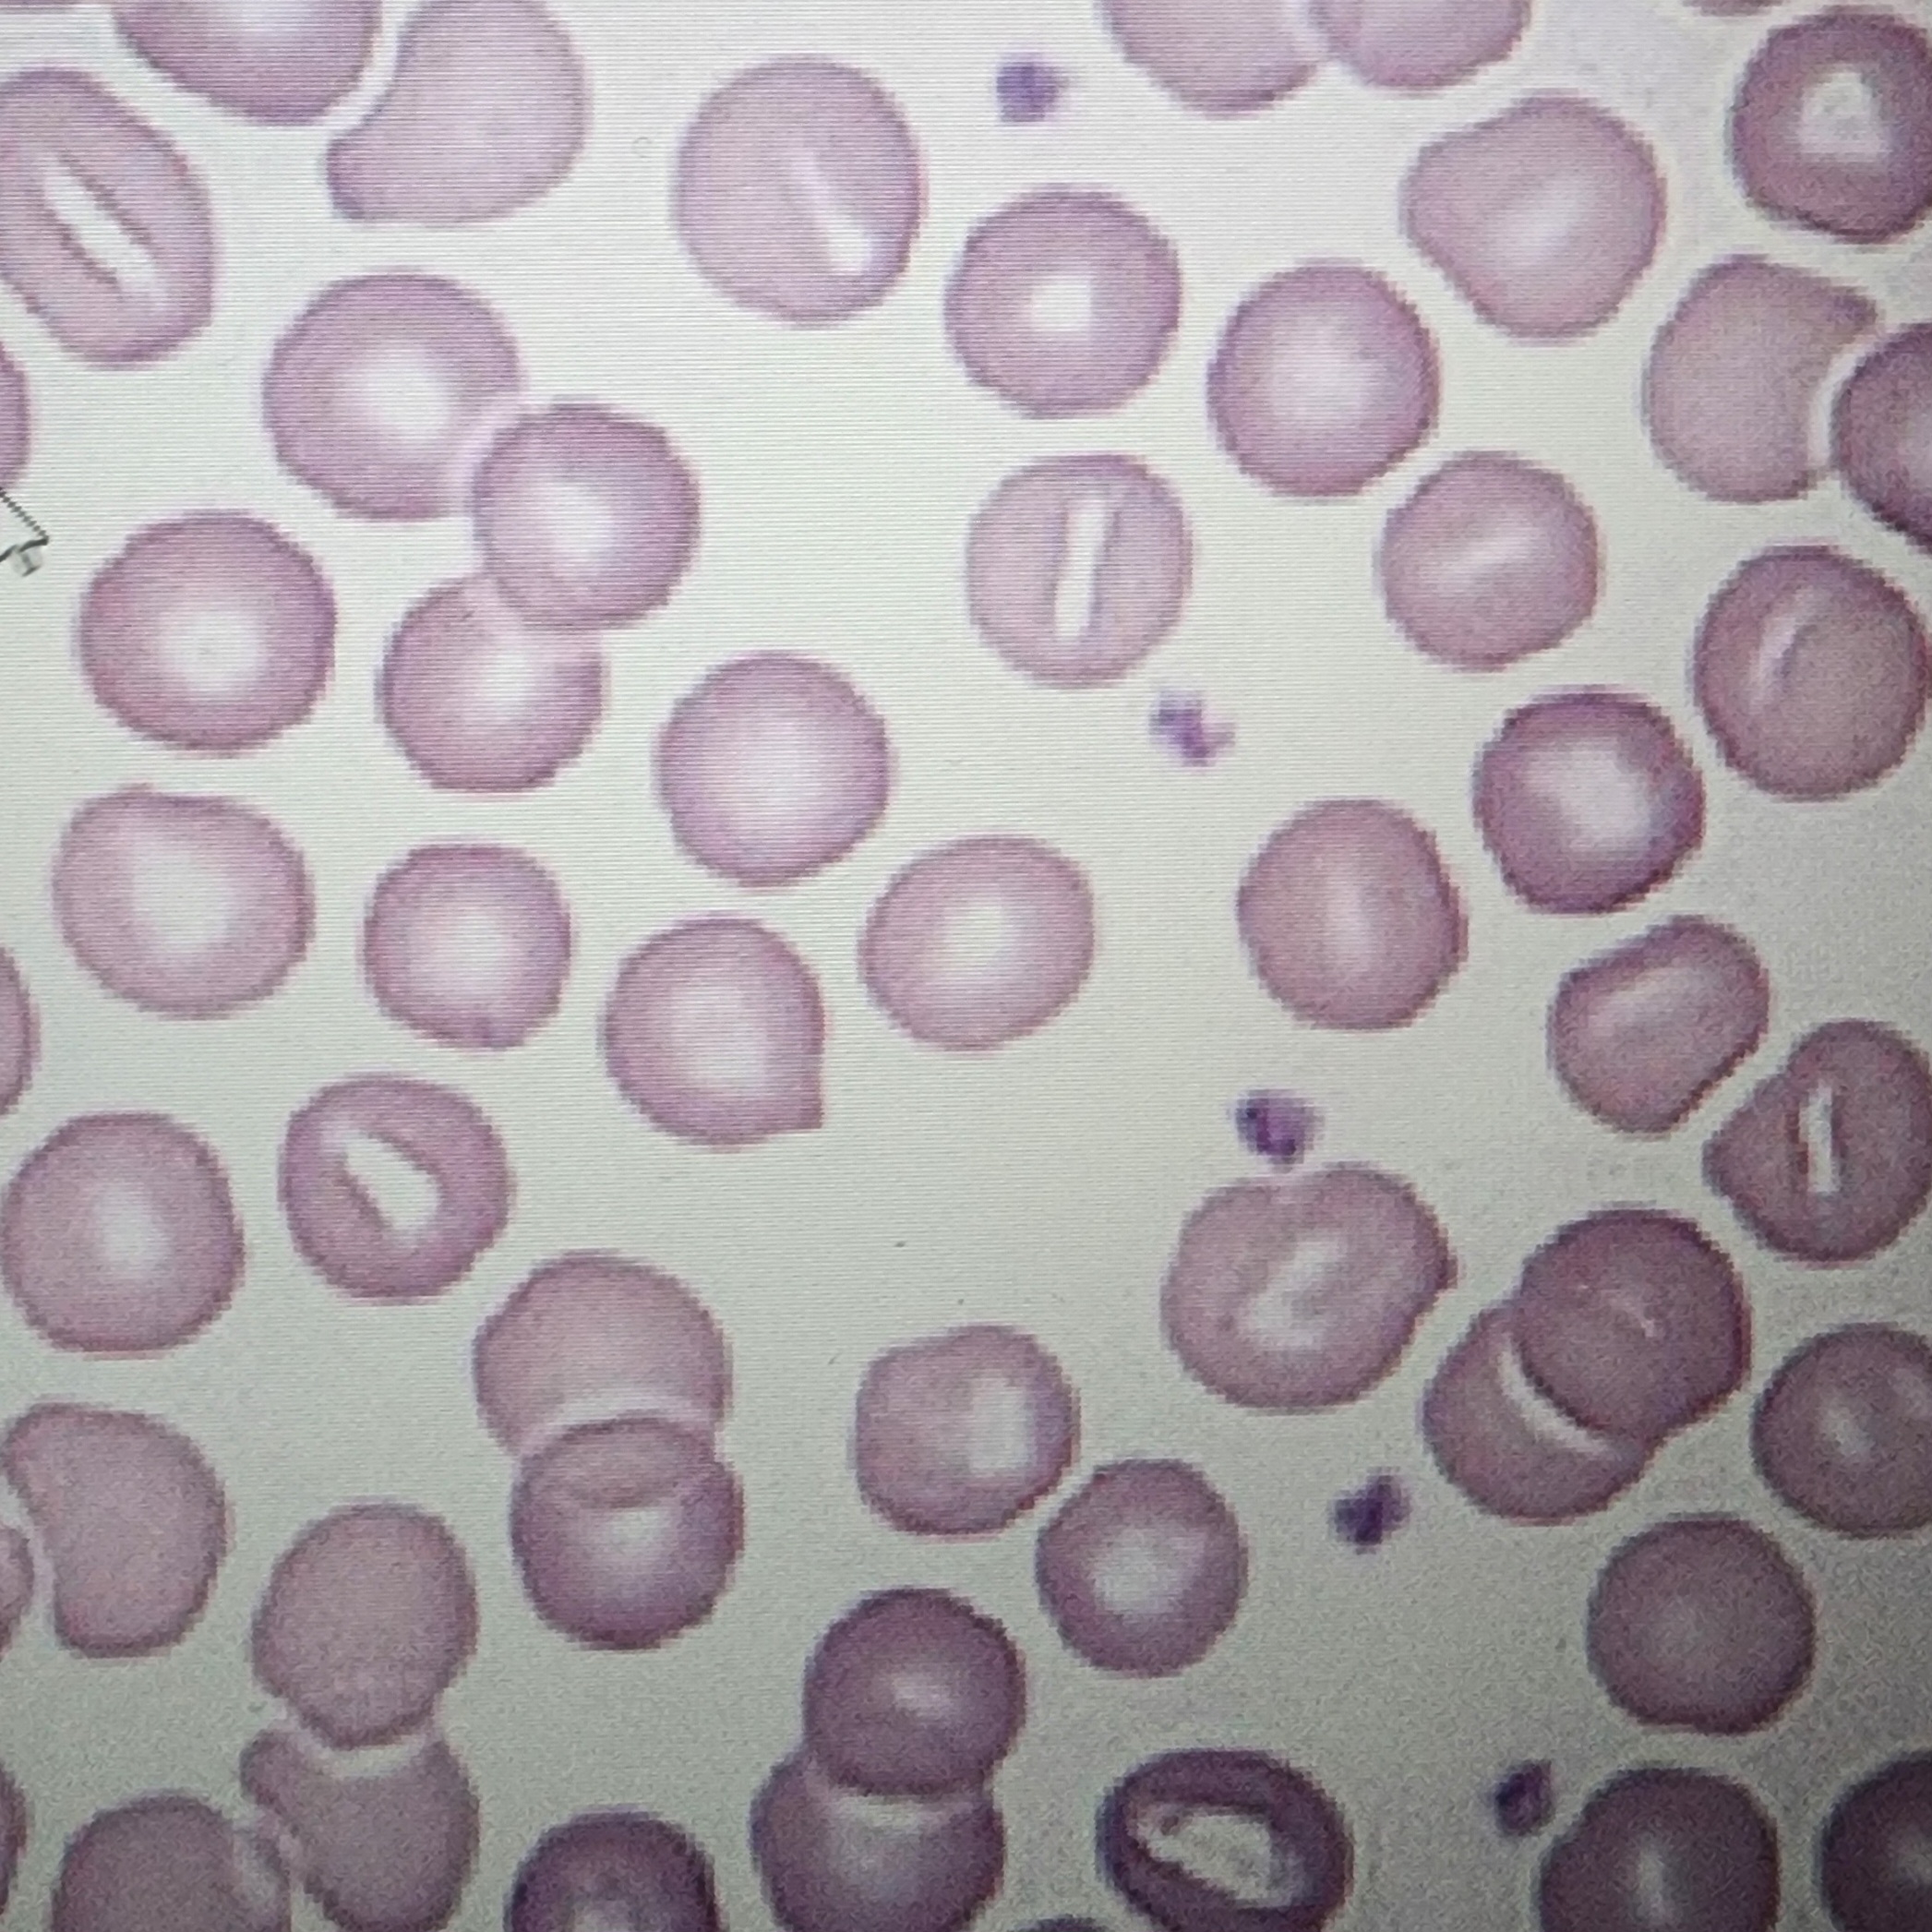
<p>Slit-like pale region in the center</p>
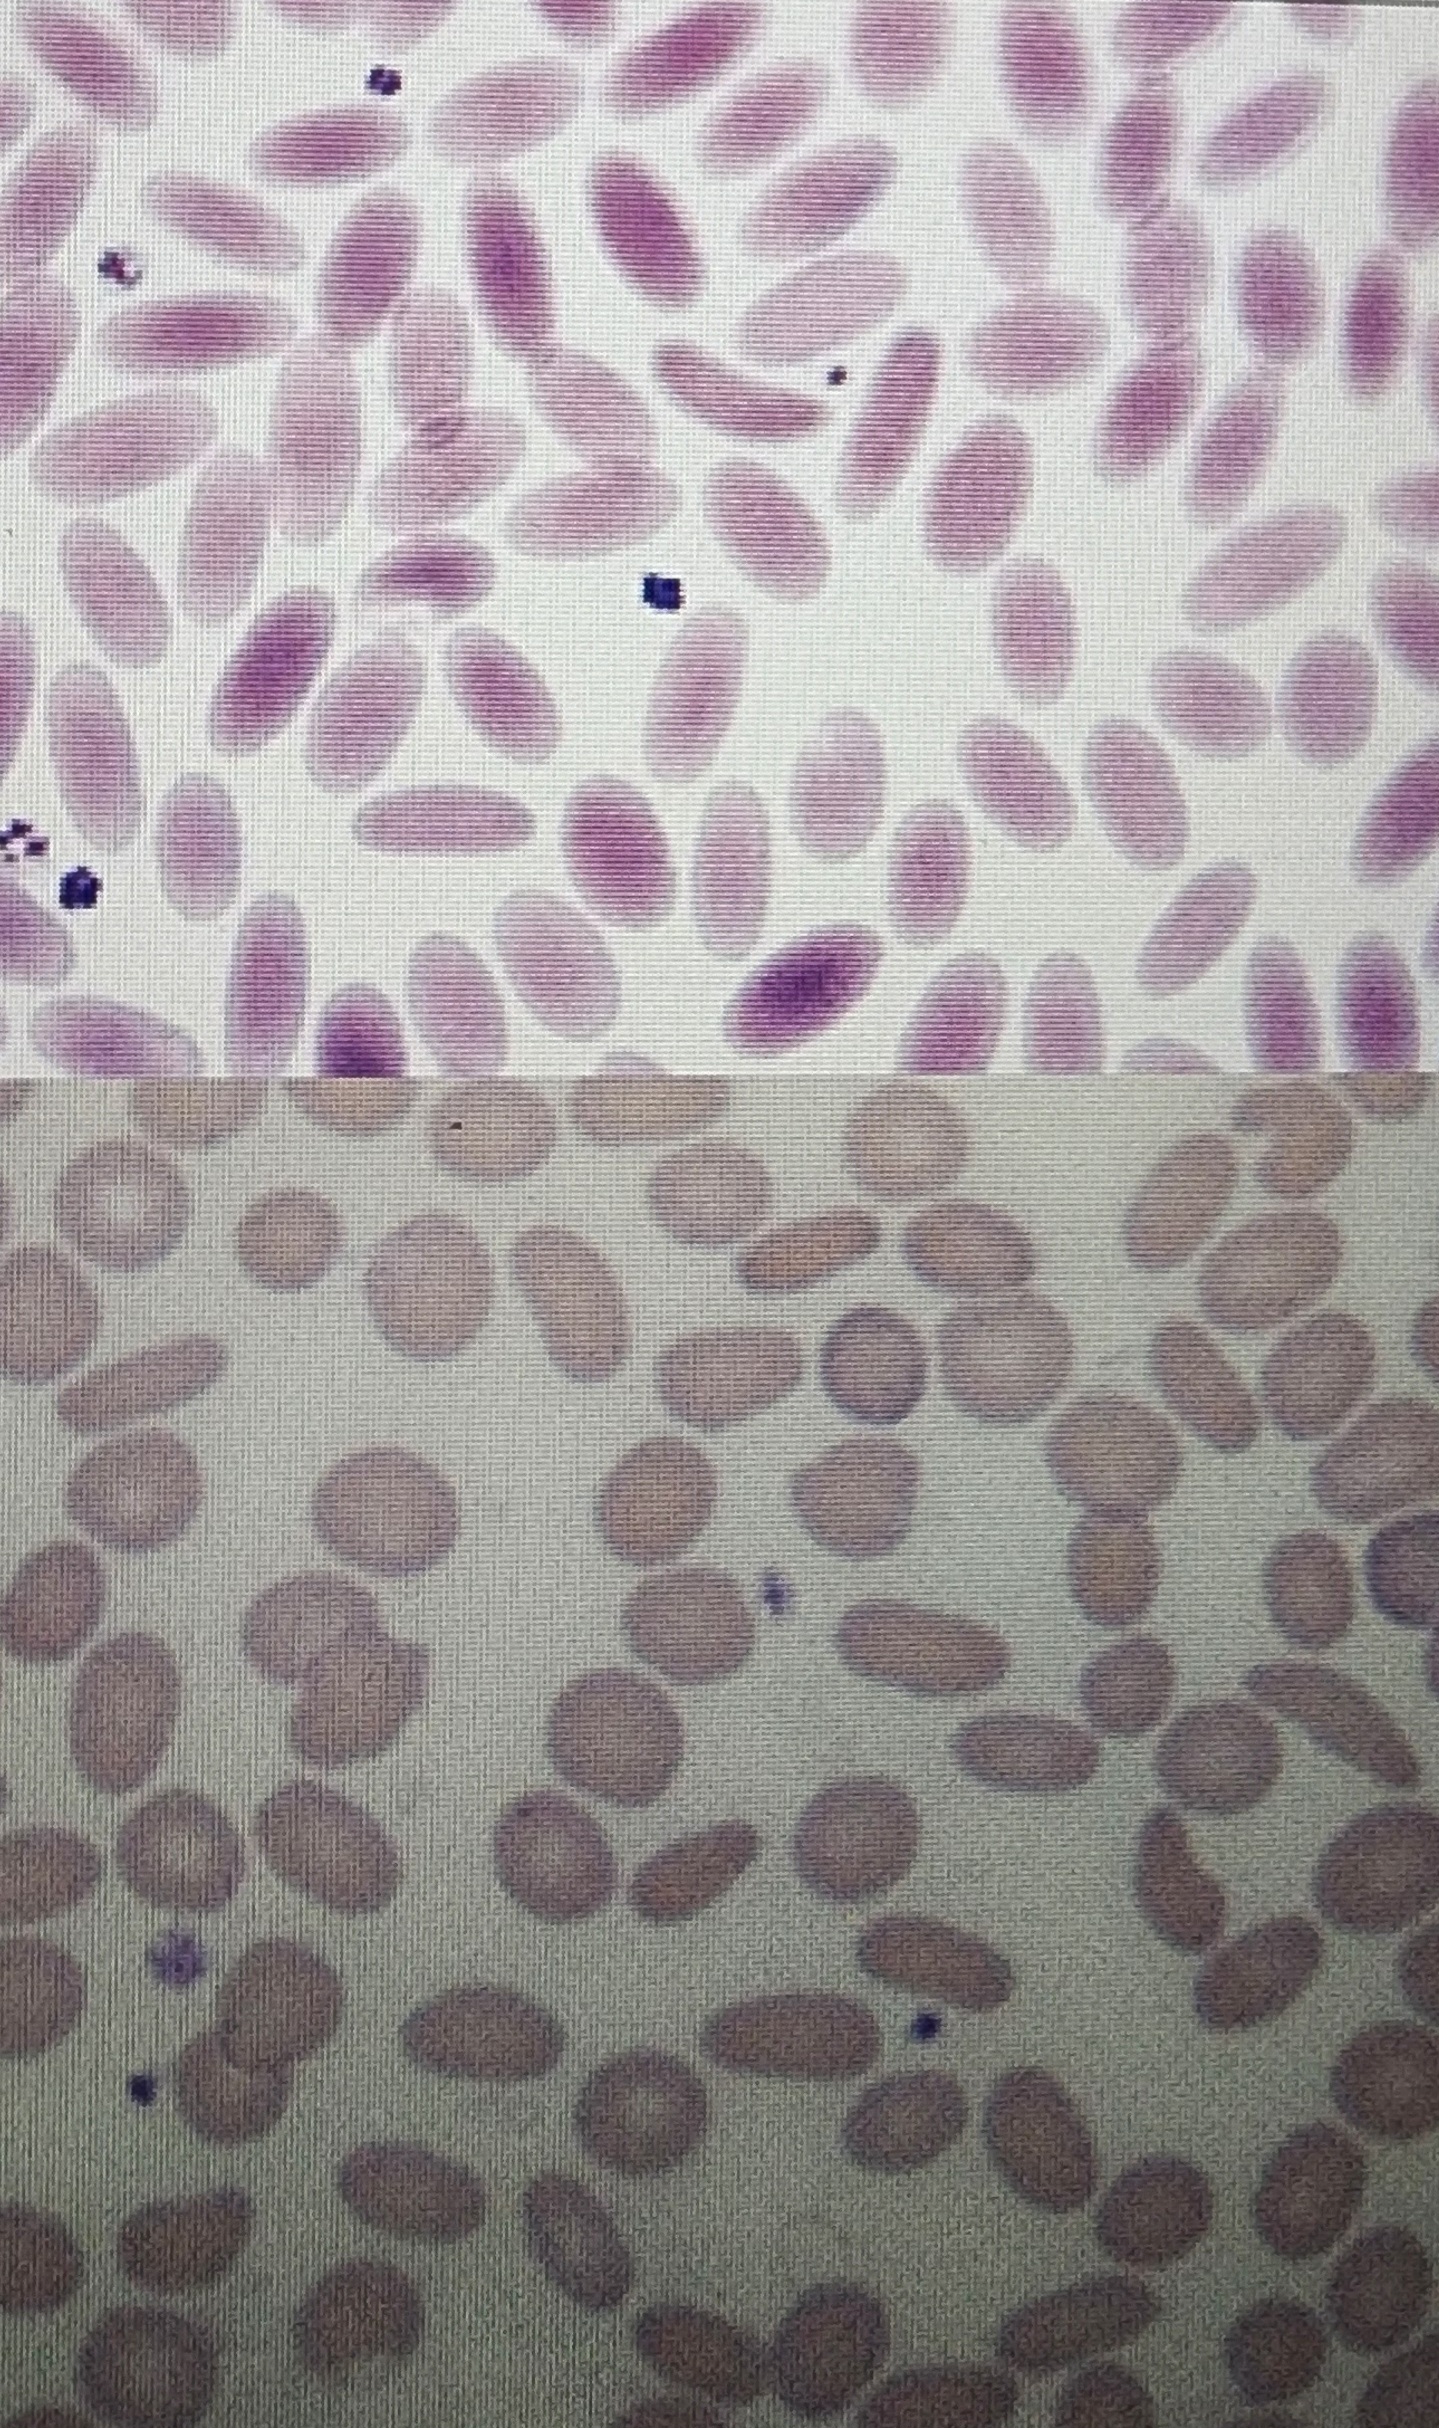
<p>Ovalocytes</p>
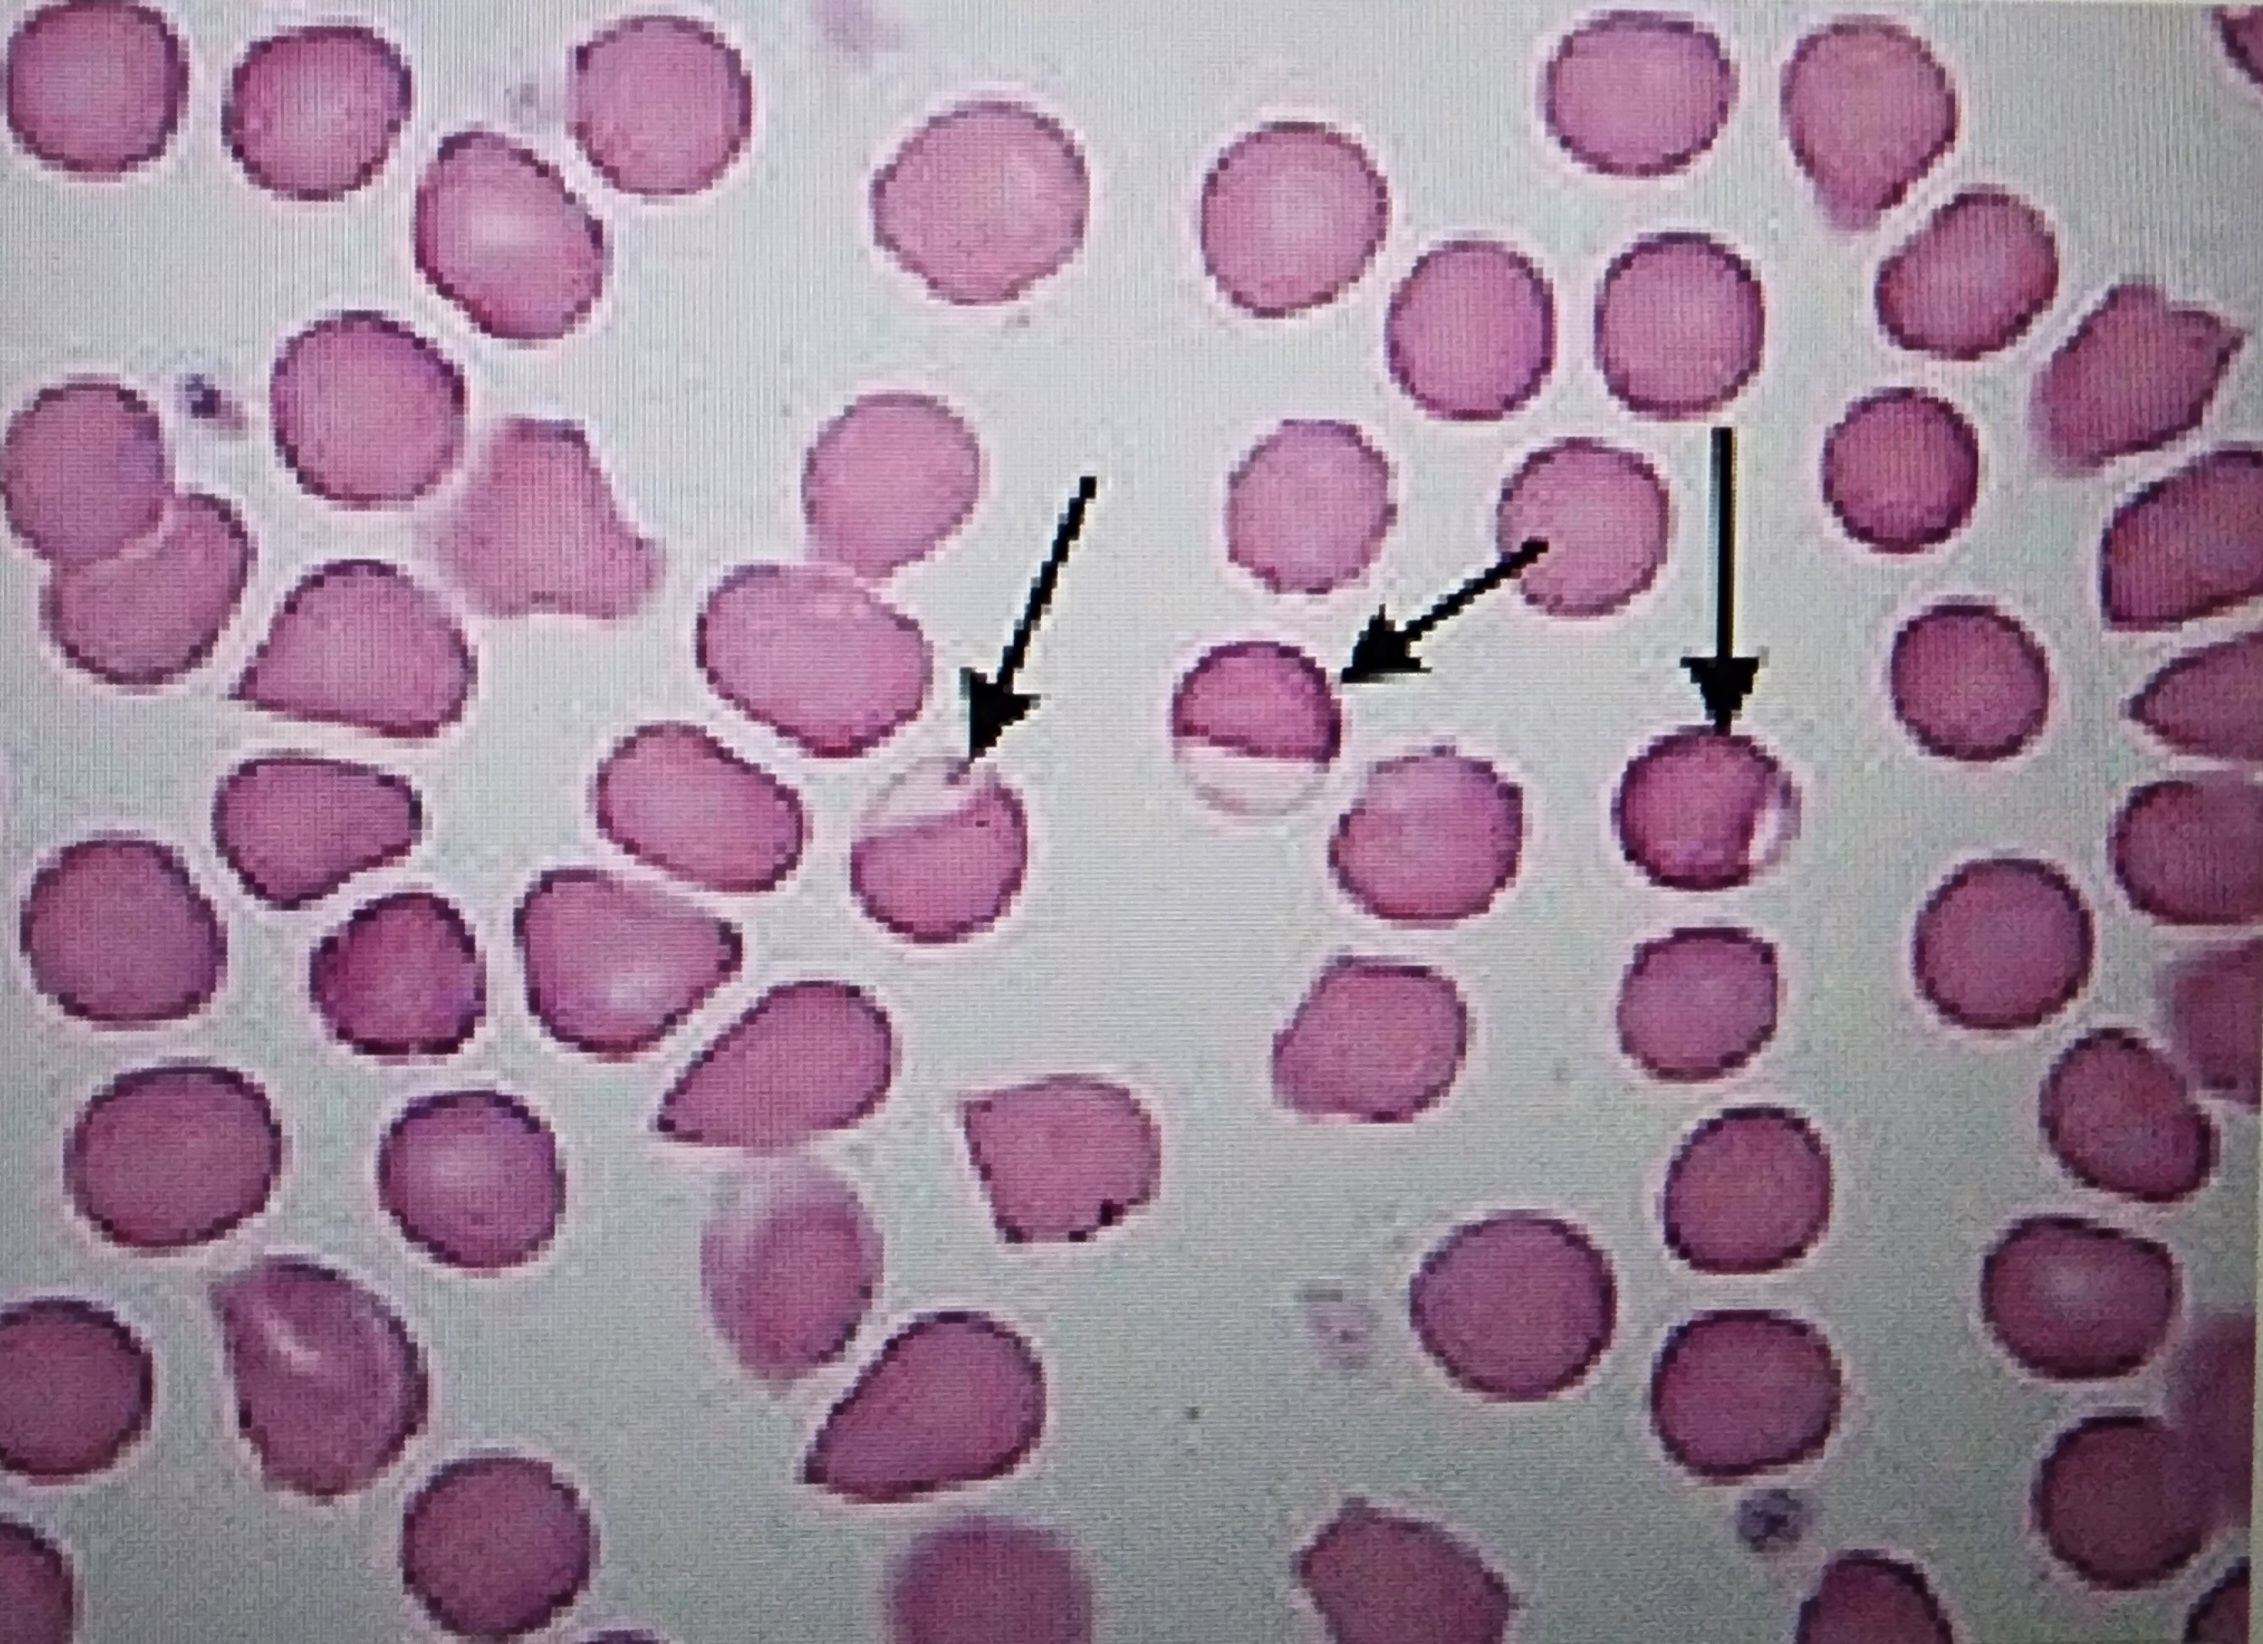
<p>fused membrane on 1 side that looks empty</p>
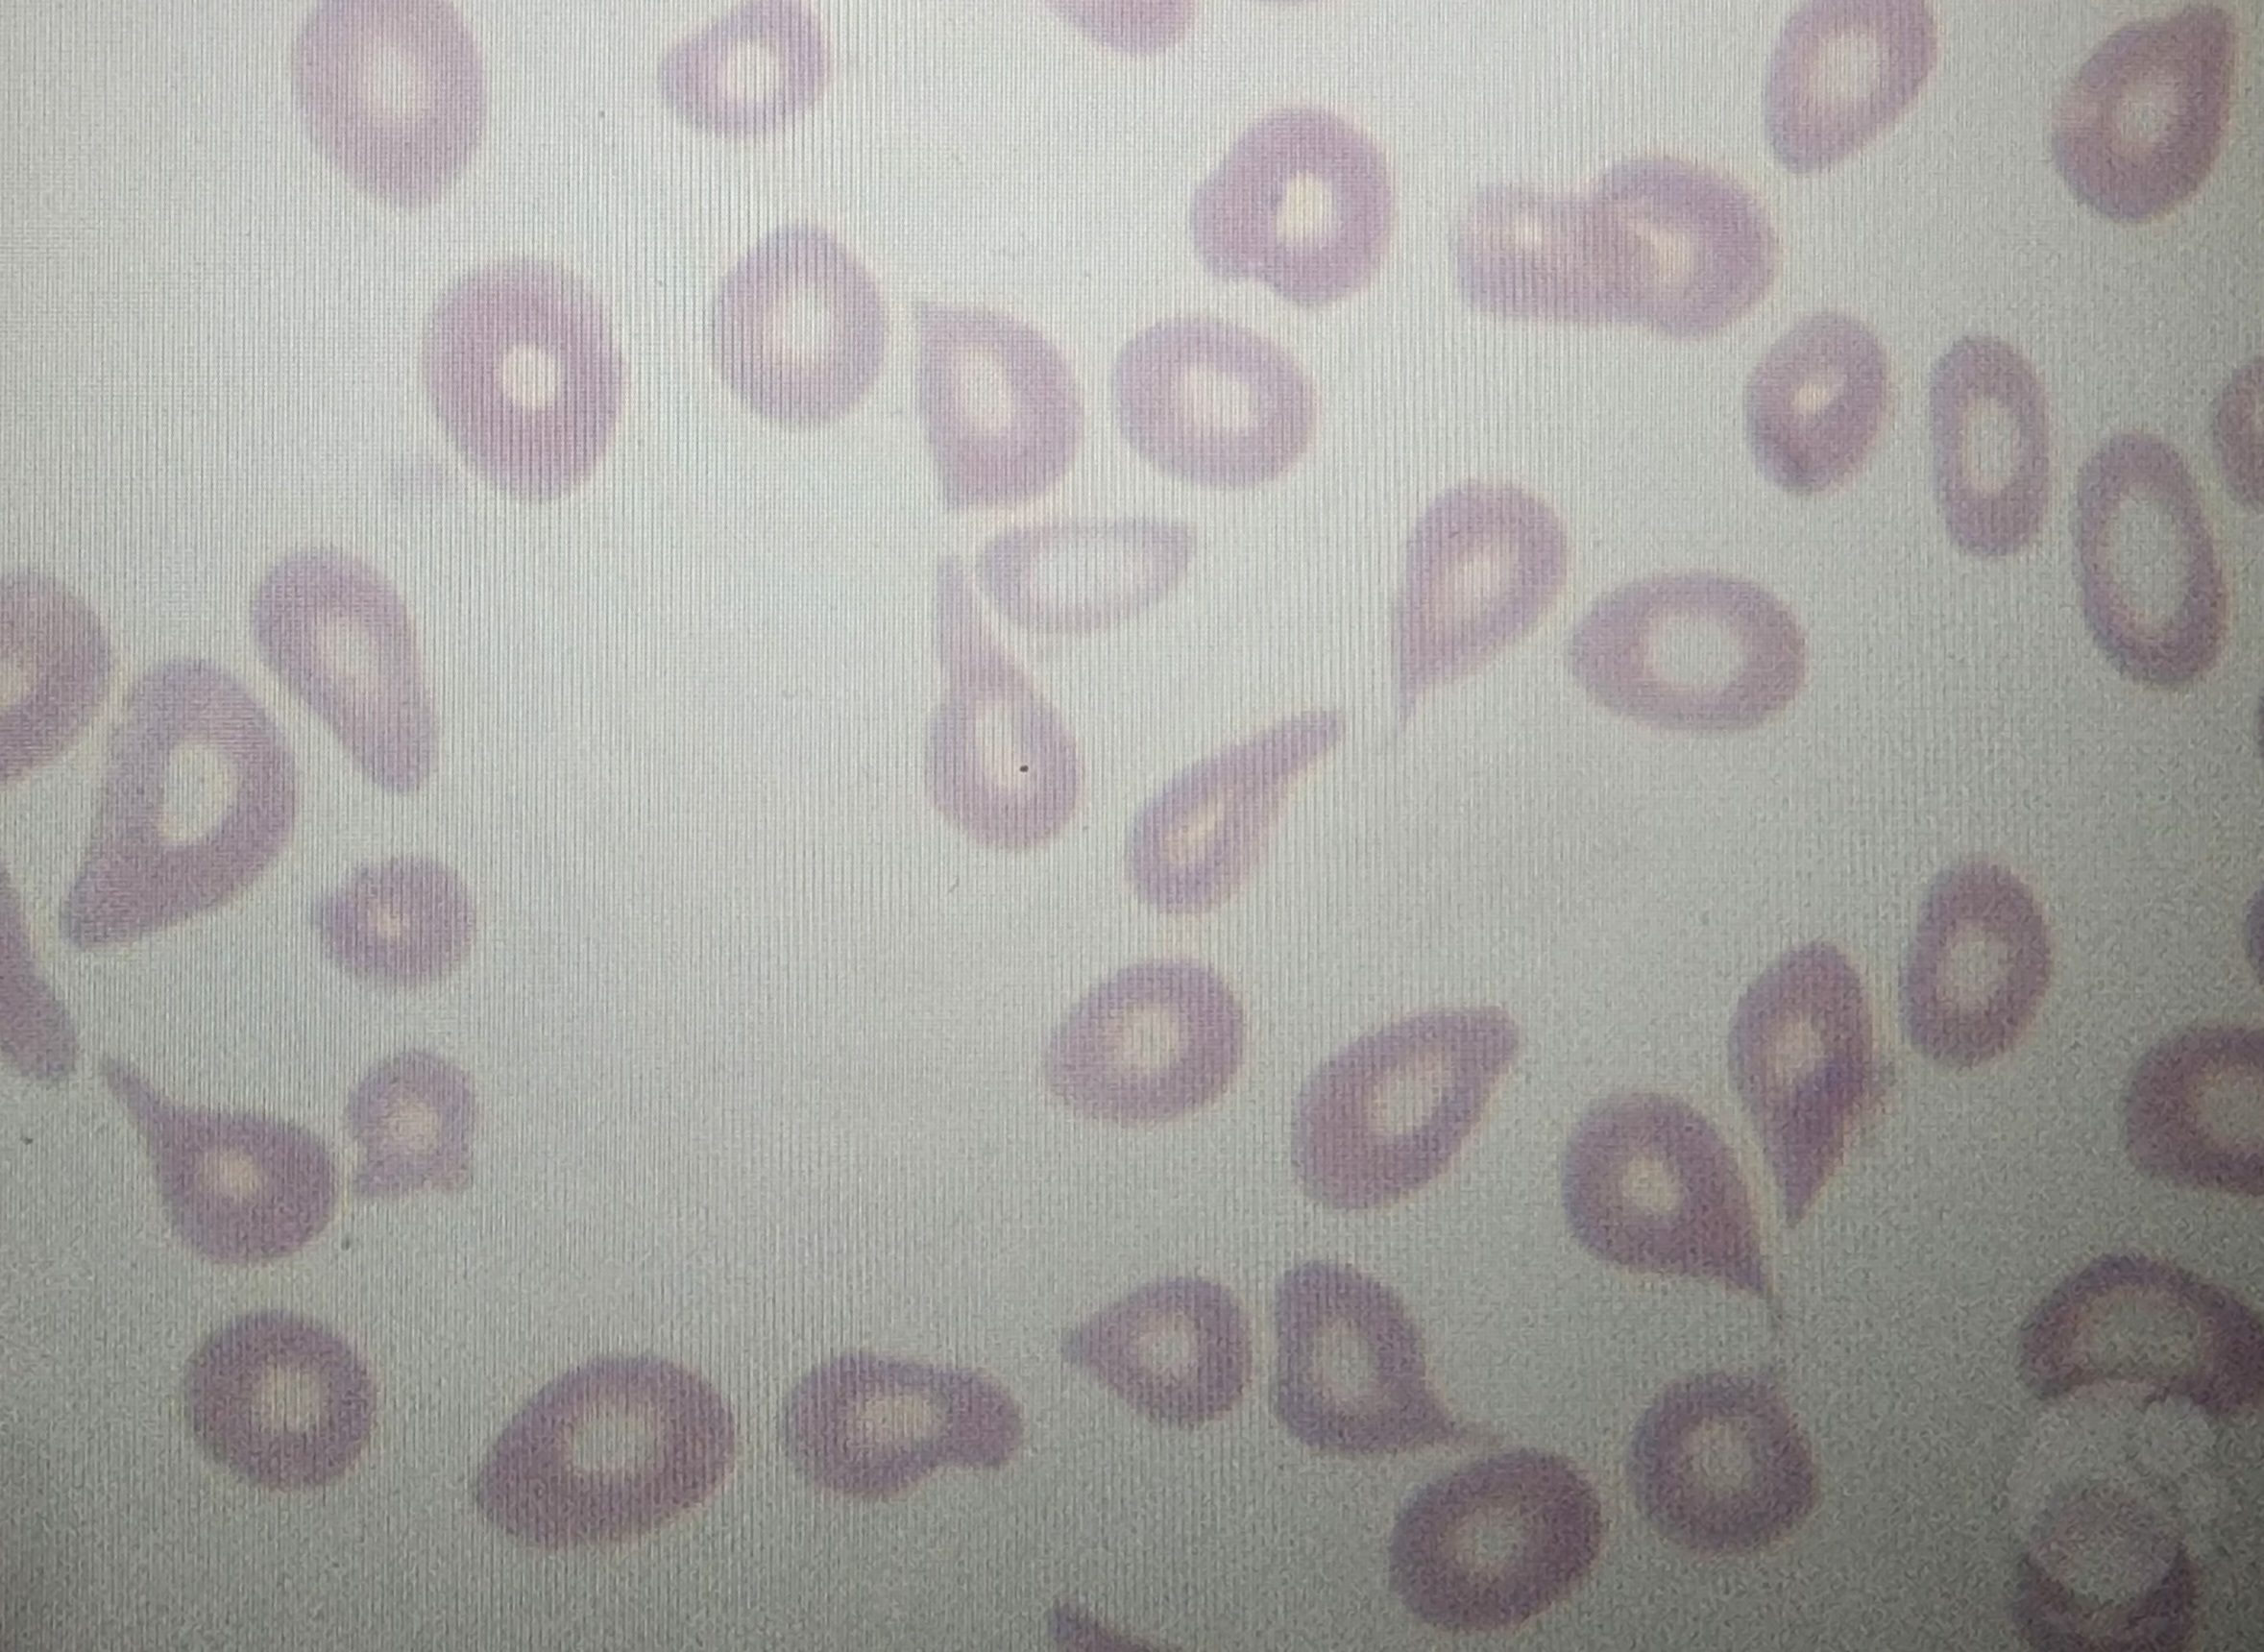
<p>Tear shaped</p>

1/21
Looks like no tags are added yet.
Name | Mastery | Learn | Test | Matching | Spaced |
|---|
No study sessions yet.
Rouleaux
coin stacking
Autoagglutination
clumping
Anisocytosis
Variation in size of RBCs
Macrocytes

Microcytes
Polychromasia
RBCs with no central palor and bigger
Hypochromasia
RBCs with less color
Hyperchromatophil
darkly stained and smaller
Spherocyte
has hyperchromatophil
Poikilocytes
generic term for any abnormalities
Schistocytes
Damaged/torn often crescent shaped

Acanthocytes
Spur cell

Echinocytes
Burr cells

Drepanocytes
Sickle shaped when blood is exposed to air
Keratocytes
Helmet, Blister, or Bite cells

Codocytes
Target cells
Stomatocytes
Slit-like pale region in the center
Leptocytes
Increased membrane surface area with more or less hemoglobin. Codocytes, Stomatocytes, and rarely Knizocytes
Elliptocytes
Ovalocytes
Eccentrocytes
fused membrane on 1 side that looks empty
Dacryocytes
Tear shaped
Knizocytes
Rare
